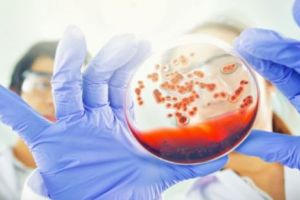
Boală din sec. XVIII, contractată de un tânăr. Simptomele

VIDEO CLUJ - Un poliţist l-a doborât la pământ şi i-a aplicat trei pumni la ficat. Vi se pare normal?
www.stiridecluj.ro - Cluj
VIDEO CLUJ - Un poliţist a doborât la pământ un bărbat şi i-a aplicat trei pumni la ficat

VIDEO CLUJ - Un poliţist l-a doborât la pământ şi i-a aplicat trei pumni la ficat. Vi se pare normal?
www.stiridecluj.ro - Cluj
VIDEO CLUJ - Un poliţist a doborât la pământ un bărbat şi i-a aplicat trei pumni la ficat

VIDEO CLUJ - Un poliţist l-a doborât la pământ şi i-a aplicat trei pumni la ficat. Vi se pare normal?
www.stiridecluj.ro - Cluj
VIDEO CLUJ - Un poliţist a doborât la pământ un bărbat şi i-a aplicat trei pumni la ficat

VIDEO CLUJ - Un poliţist l-a doborât la pământ şi i-a aplicat trei pumni la ficat. Vi se pare normal?
www.stiridecluj.ro - Cluj
VIDEO CLUJ - Un poliţist a doborât la pământ un bărbat şi i-a aplicat trei pumni la ficat

Academia Română i-a conferit lui Aurel Ardelean Medalia de Argint – „General Henri Mathias Berthelot“
newsar.ro - Arad
Citeşte azi ce scriu ziarele de mâine!

Accident surprins de camere! Motociclist in stare grava dupa ce a intrat intr-un camion
www.tion.ro - Timiş
Accident teribil, în localitatea timişeană Maşloc. Un motociclist a ajuns în stare gravă la spital, după ce s-a izbit în plin de un autocamion. Momentul impactului a fost surprins de camerele de supraveghere montate în centrul localităţii, iar imaginile au devenit virale pe internet.

Zona Traian, intr-un oras paralel? Robu: Nu e realitatea Timisoarei, ne-ar invidia Parisul
www.tion.ro - Timiş
Deprimant! Acesta este cuvântul care descrie zona Traian din Timişoara, un loc care s-a umplut de răufăcători, gropi în carosabil şi trotuare, case dărăpănate, miros irespirabil şi mizerie. Primarul Timişoarei spune că n-a mai trecut de multă vreme prin zonă, cam de câteva săptămâni. Mai mult, susţine că zona Traian nu prezintă realitatea oraşului Timişoara şi că ne-ar invidia Parisul dacă ar ajunge la stadiul la care noi suntem cu zona centrală. Traian nu este însă aşa departe de centru...

Masini avariate de un copac ce s-a prabusit peste ele, la Timisoara
www.tion.ro - Timiş
Intervenţie a pompierilor pe strada Mareşal Alexandru Averescu, la Timişoara. Salvatorii au fost chemaţi să intervină, după ce un copac s-a prăbuşit pe trei autoturisme parcate.

Proiectii 3D pe apa, la Surduc. Concursuri, ture cu bicicleta si muzica, duminica, la Zilele Lacului
www.tion.ro - Timiş
Evenimentele continuă la Surduc, după o seară cu concerte, proiecţii pe apă şi foc de artificii. Zilele Lacului Surduc merg înainte şi duminică, cu diverse activităţi pe lac şi în jurul lui şi muzică populară. Vor fi concursuri pe lac, teatru pentru copii şi ateliere meşteşugăreşti.

Economia judetului Timis ramane fara numeroase afaceri
www.tion.ro - Timiş
Peste 1.200 de afaceri nu mai produc pentru economia Timişului după primele patru luni ale acestui an. Numărul de firme şi persoane fizice autorizate care şi-au închis sau suspendat activitatea în această perioadă în cel mai vestic judeţ al ţării a crescut spectaculos.

Blazzaj a stralucit in alb pe scena de la Timisoara Craft Beer Festival. Surprizele de duminica
www.tion.ro - Timiş
Concert extraordinar susţinut de Blazzaj, sâmbătă seară, în Parcul Rozelor. Timişorenii au strălucit, îmbrăcaţi în tricouri albe, pe scena de la Timişoara Craft Beer Festival. 20 de microberării artizanale şi doi producători de cidru craft vă aşteaptă şi duminică în parc, la ultima zi de festival.

Cod galben in Timisoara si in judet: ploi in averse, intensificari ale vantului si grindina
www.tion.ro - Timiş
Cod galben de vreme rea în Timiş. Meteorologii anunţă ploi în averse, intensificări ale vântului, dar şi grindină de mici dimensiuni. Avertizarea este valabilă pentru centrul şi estul judeţului.

“Maladiile” informatice blochează activitatea cabinetelor şi pun pacienţii pe drumuri: Medicii s-au săturat să fie conţopişti!
obiectivvaslui.ro - Vaslui
“De multe ori, serviciile medicale contractate (reţete şi trimiteri – n.r.) nu sunt validate pentru că validarea se face după un filtru de maximum 72 de ore, termen care, din cauza întreruper…

Primarul Dumitru Boroş iese pe teren: Investiţiile, verificate la sânge
obiectivvaslui.ro - Vaslui
Edilul şef al Bârladului inspectează personal lucrările de construcţii la obiectivele de interes public. Prima oprire a fost la cele două sere.

Când vin şi cum vor putea fi folosite? O nouă “specie” de vouchere – tichetele culturale!
obiectivvaslui.ro - Vaslui
Pe lângă tichetele de masă, tichetele cadou, tichetele de creşă şi voucherele de vacanţă, vor apărea şi tichetele culturale. Propunerea legislativă urmează să fie promulgată de preşedintele Klaus I…

Grădiniţele, deschise şi în vacanţă: Unde-şi duc părinţii vasluieni copiii?
obiectivvaslui.ro - Vaslui
La nivelul ISJ Vaslui, s-a realizat deja planificarea activităţii grădiniţelor cu program prelungit pe perioada vacanţei de vară. În municipiul Vaslui, atât în luna iulie, cât şi în august, vor fi …

Start proiectului cultural “100 de ani de Unire, 100 de ani de folclor muzical”: “Trandafir de la Moldova” şi Marea Unire
obiectivvaslui.ro - Vaslui
“Nu pot decât să vă felicit pentru activitatea pe care o desfăşuraţi şi în care încercaţi să ţineţi vii tradiţiile populare. Nu este deloc uşor să ţii o grupă de copii lângă tine ani la rând, să-i …

Răsfoind presa de altădată (63): La piaţă, ca la bâlci!
obiectivvaslui.ro - Vaslui
O situaţie asemănătoare găsise în periplul său „şi la centrele de distribuire a cărnii nr. 25 şi 44 ale organizaţiei comerciale locale «Alimentara» (responsabili Mihai Damian şi Vasile Gheorghiţă)”…

Start la recoltare!
obiectivvaslui.ro - Vaslui
Vasluiul este unul dintre judeţele în care s-a dat deja startul campaniei de recoltat la orz, iar specialiştii Direcţiei pentru Agricultură Judeţeană (DAJ) susţin că lucrările sunt în grafic. Până …

Fermierii vasluieni, invitaţi în Uniunea Naţională a Cooperativelor Agricole
obiectivvaslui.ro - Vaslui
Potrivit directorului Direcţiei pentru Agricultură a Judeţului (DAJ) Vaslui, Gigel Crudu, toate cooperativele, asociaţiile, companiile şi persoanele fizice care activează în domeniul “agricul…

Apă rece pentru bârlădenii aflaţi la plimbare
obiectivvaslui.ro - Vaslui
De joi, 14 iunie, punctele de prim-ajutor şi distribuţie a apei instalate în Bârlad în special în zilele cu temperaturi infernale au început să funcţioneze. Este vorba despre un cort anti-caniculă,…

Concursurile serviciilor pentru situaţii de urgenţă
obiectivvaslui.ro - Vaslui
În Poligonul de pregătire al Inspectoratului pentru Situaţii de Urgenţă (ISU) „Podul Înalt” al judeţului Vaslui s-a desfăşurat etapa judeţeană a concursurilor profesionale ale serviciilor voluntare…

Spitalul Huşi caută director medical
obiectivvaslui.ro - Vaslui
Conducerea Spitalului Municipal “Dimitrie Castroian” din Huşi a anunţat că organizează concurs pentru ocuparea postului de director medical. Termenul limită de depunere a dosarelor de înscriere est…

Înscrieri în învăţământul profesional
obiectivvaslui.ro - Vaslui
Înscrierea pentru clasele de învăţământ profesional din anul şcolar 2018-2019 a început pe 15 iunie. Mâine vor fi publicate listele cu elevii înscrişi, iar joi şi vineri vor fi susţinute probele el…

“Sanitarii pricepuţi”
obiectivvaslui.ro - Vaslui
La etapa judeţeană a Concursului pentru Sănătate şi Prim-Ajutor „Sanitarii Pricepuţi”, au participat opt echipaje de gimnaziu şi liceu.

“Agro” Huşi a stabilit calendarul corigenţelor
obiectivvaslui.ro - Vaslui
Elevii din clasele terminale de liceu vor susţine testele în perioada 23-24 iulie, iar cei cu situaţia neîncheiată, în intervalul 18-22 iunie.

Încep controalele estivale
obiectivvaslui.ro - Vaslui
Până la finele lui august, echipe de inspectori din cadrul Direcţiei Sanitare Veterinare şi pentru Siguranţa Alimentelor Vaslui vor lua la puricat zonele de agrement din judeţ.

Vicecampionii României
obiectivvaslui.ro - Vaslui
Handbaliştii juniori IV de la LPS Vaslui au obţinut o performanţă remarcabilă la Baia Mare, devenind vicecampioni naţionali.

Flacăra, noua campioană a Vasluiului!
obiectivvaslui.ro - Vaslui
Flacăra Muntenii de Sus a câştigat finala ligii a patra cu FC Gârceni, scor 2-1, graţie golurilor marcate de Cosovăţ şi Gabriel Crăciun. Victoria a fost una cu emoţii! Gârcenenii au dominat clar re…

Anthony Robbins: Putere nemărginită (XI): Convingerile-cheie
obiectivvaslui.ro - Vaslui
Întâmplări, extraordinare sau banale, pot ajuta la formarea convingerilor. În viaţa fiecăruia există întâmplări pe care nu le poate uita niciodată. Unde vă aflaţi în ziua în care a fost ucis John F…

„Caravana Cireşarilor”, la prima ediţie
obiectivvaslui.ro - Vaslui
Biblioteca Municipală „Stroe S. Belloescu” Bârlad a organizat o inedită activitate de comemorare a scriitorului Constantin Chiriţă, autorul celebrului ciclu de romane „Cireşarii”, născut pe 12 mart…

Cea mai bună junioară din ţară!
obiectivvaslui.ro - Vaslui
Cristina Balaur este dublă campioană naţională la atletism junioare 2, după ce a câştigat probele de 1.500 m şi 3.000 m.

Misiune dificilă
obiectivvaslui.ro - Vaslui
Comstar Vaslui se va duela cu Viitorul Constanţa, Prosport Academy Bucureşti şi FC Argeş Piteşti pentru un loc în finala Campionatului Naţional de fotbal U13.

Gimnaste din Torino, în vizită la Bârlad
obiectivvaslui.ro - Vaslui
În intervalul 20-29 iunie, un grup de gimnaste din Torino, Italia, antrenate de Alina Pascariu, o fostă gimnastă din Bârlad, se vor pregăti în sala de antrenamente „Andreea Răducan” a Clubului Spor…

Turneu de şah la Huşi
obiectivvaslui.ro - Vaslui
Clubul de şah “Gambit” Huşi, cu sprijinul Consiliului Judeţean (CJ) Vaslui, organizează, în perioada 23-24 iunie, prima ediţie a “Cupei Gambit Huşi”. Evenimentul va avea loc la Cercul Militar Huşi.…

Românii din diaspora au pus tunurile pe „Charlie Hebdo”
evz.ro - Bucureşti
Publicaţia satirică din Franţa i-a înfuriat la maximum pe românii din străinătate, după ce a publicat caricatura Simonei Halep cu trofeul Roland Garros în b...

CAMPIONATUL MONDIAL. CURG SURPRIZELE la turneul din Rusia. Brazilia a fost BLOCATĂ de Elveţia
evz.ro - Bucureşti
Naţionala Braziliei a debutat cu o remiză, la turneul final din Rusia, după ce a încheiat cu scorul de 1-1 confruntarea jucată contra Elveţiei....

Punct şi de la capăt pentru Comarnic-Braşov
evz.ro - Bucureşti
Guvernul nu va mai realiza cu asistenţa Băncii Mondiale autostrada A3 Ploieşti – Comarnic - Braşov, ci va merge din nou - pentru a patra oară - pe ideea unu...

Succes al filmului românesc în Spania
evz.ro - Bucureşti
Scurtmetrajul românesc „Miss Sueno”, al regizorului Radu Potcoavă, a câştigat premiul cel mare al Festivalului Internaţional de Film Huesca, din Spania. Urm...

Ce s-ar fi întâmplat dacă Napoleon Bonaparte ar fi câştigat bătălia de la Waterloo? Horoscop
evz.ro - Bucureşti
Horoscop „Evenimentul Zilei” din 18 iunie 1815 a fost marea bătălie de la Waterloo. O armată pestriţă a alianţei „celor şapte” condusă de un general...

Laura Andros: «Eu cred în vocea sufletului meu»
www.desteptarea.ro - Bacău
De când ne naştem şi până părăsim această lume comunicăm şi relaţionăm cu semenii noştri. Se poate spune că spiritul uman este definit şi prin felul în care noi am ales să comunicăm. Această formă de legătură dintre semeni a evoluat şi ea o dată cu vremurile, definindu-ne sau alterându-ne spiritul. Iar jurnalismul, un gen …

UE se duce
www.desteptarea.ro - Bacău
Uniunea Europeană este pe moarte. Și moare urât. Nu trebuie să fii profet ca să vezi semnele. Mai întâi a fost fronda esticilor de la Vişegrad. Pe urmă îngenuncherea Greciei. Apoi nebunia Brexitului. Radicalizarea Austriei. Euroscepticismul Italiei. Germania vine puternic din urmă şi se pregăteşte să o execute politic pe Frau Merkel, în vreme ce …

Jazz-ul a răsunat trei zile în Bacău
www.desteptarea.ro - Bacău
Parcul Cancicov nu a fost niciodată mai frumos ca acum! Inima lui a vibrat pe ritmuri de jazz, iar zona centrală a fost decorată cu ghirlande, panglici, flori, decoraţiuni temporare, baloane şi steluţe. Detaliile nonconformiste şi muzica de calitate le-au oferit băcăuanilor o bulă de oxigen atât de necesară în spaţiul cultural al comunităţii. Vineri, …

Novac, de neoprit!
www.desteptarea.ro - Bacău
Mihăiţă Alexandru Novac este de neoprit. Suliţaşul legitimat la CSM Bacău câştigă competiţie după competiţie. Și bate record după record. Ultima reuşită s-a produs vineri seara, la cea de-a 27-a ediţie a Trofeului „Toni Fallai”, miting atletic internaţional care are loc anual, în Italia, la Conegliano, lângă Treviso. Novac a confirmat ascensiunea sa remarcabilă, câştigând …

Educaţie prin cultură
www.desteptarea.ro - Bacău
Timp de trei zile, în Parcul Cancicov s-a cântat jazz. Sunt convinsă că la auzul denumirii acestui gen muzical mulţi strâmbă din nas, dezaprobator. Despre această categorie de oameni nu pot decât să spun că nu au ascultat jazz în compania persoanei potrivite. Despre mine pot să spun că jazz-ul mi-a mers direct la suflet. …

Liberalii lui Ludovic Orban pierd săptămânal parlamentari
evz.ro - Bucureşti
Senatorul Daniel Zamfir s-a înscris în ALDE. Fostul PNL-ist s-a prezent, ieri, alături de Călin Popescu-Tăriceanu, la conferinţa de presă susţinută de preşe...

Despre DEPRESIA copiilor şi adolescenţilor. Cu românul la PSIHOLOG
evz.ro - Bucureşti
Depresia apare la 1%-2% dintre copii înainte de pubertate. Puteţi vedea chiar şi depresie la preşcolari, deşi nu este aşa comună. Aceasta se întâmplă de obi...

Imigranţii adoptaţi îi clatină scaunul lui Merkel
evz.ro - Bucureşti
Angela Merkel simte pericolul plutind în aer şi şacalii atât aşteptă, să atace când percep mirosul sângelui. Ea convoacă o reuniune de urgenţă cu statele di...

Ce a răspuns MAI la întrebarea care a născut cea mai mare DILEMĂ
evz.ro - Bucureşti
Angajaţii de la MAI au reuşit în weekend să fie şi amuzanţi, şi isteţi, dând un răspuns unui internaut preocupat de o formulă matematică. Poliţiştii ministe...

Sfântul zilei. Trei soldaţi
evz.ro - Bucureşti
Leontie, Ipatie şi Teodul au fost soldaţi romani în timpul împăratului Vespasian (69-79). Leontie, grec de origine, era comandant de armată în oraşul fenici...

O zecime din populaţia Islandei, la Mondialul din Rusia
evz.ro - Bucureşti
Nordicii au luat cu asalt primul lor turneu final din istorie. Peste 30.000 de „vikingi” s-au deplasat în Rusia pentru a-şi susţine naţionala, cea care, sâm...

Traian Băsescu a părăsit brusc PMP: „Mă simt eliberat!”
evz.ro - Bucureşti
16 iunie 2018! Ziua în care Traian Băsescu a plecat de la conducerea Partidului Mişcarea Populară, astfel încât să-şi poată spune oful „Mă simt eliberat”, a...

Judecătoarea Dana Gîrbovan despre revocarea şefei DNA: „Dacă Preşedintele încalcă legea, de ce ar mai fi aceasta respectată de restul cetăţenilor?”
evz.ro - Bucureşti
Preşedinta Uniunii Naţionale a Judecătorilor din România (UNJR), magistratul Dana Gîrbovan, a analizat pentru „Evenimentul Zilei” situaţiile tensionate din ...

Cu un buget de 24,5 milioane de euro pe 3 ani, Guvernul reia serviciile de asistenţă pentru bătrânii singuri pe lume
evz.ro - Bucureşti
Cazurile bătrânilor care se sfârşesc în singurătate sunt tot mai dese, aşa că Ministerul Muncii a compus şi deja a fost şi aprobat în guvern o Hotărâre care...

De ce nu îl vrea Dragnea pe Vlase la şefia SIE. Planul şefului PSD
evz.ro - Bucureşti
Deşi nu s-a hotărât încă să susţină un alt nume din PSD, Liviu Dragnea blochează învestirea deputatului social-democrat Gabriel Vlase în funcţia de director...

„Evazatul” intră la igienizare şi modernizare!
www.desteptarea.ro - Bacău
După numeroase atenţionări, pe care oneştenii le-au făcut autorităţilor locale, semnalând faptul că blocul Evazatul (de pe str. Libertăţiii din Oneşti) este un adevărat focar de infecţie, primarul municipiului Nicolae Gnatiuc dă o veste bună locatarilor acestui imobil. El a menţionat că „în zilele următoare va demara o amplă lucrare ce vizează atât igienizarea parterului …

Nu rataţi noul BIHOREANUL tipărit!
www.ebihoreanul.ro - Bihor
Luni, 18 iunie, a apărut un nou număr din BIHOREANUL tipărit, alături de suplimentul ecologic Oradea Noastră. Dintre subiectele noii ediţii: O companie a milionarului Viorel Micula plănuieşte să ridice în Piaţa Cetăţii un complex imobiliar fără egal, cu un turn de 19 etaje, de două ori mai înalt decât orice bloc din Oradea. BIHOREANUL vă prezintă în exclusivitate proiectul ce prevede un ansamblu comercial şi locativ cu blocuri de 19, 16 şi 13 etaje, fiecare cu parcări subterane pe două niveluri, cu piscină şi sute de apartamente, ce vor domina zona de la 67 metri altitudine, dar care a stârnit

Fotbal – CM 2018: Brazilia, doar egal cu Elvetia, 1-1
ziarmm.ro - Maramureş
Brazilia, una dintre favoritele Cupei Mondiale de fotbal din Rusia, a reusit doar un rezultat de egalitate cu Elvetia 1-1 (1-0), duminica seara, pe Rostov Arena din Rostov pe Don, in Grupa E a competi

Editorial: Circuitul inchis al performantei, doar un vis?
www.ziuaconstanta.ro - Constanţa
Anii si generatiile trec, performantele se mentin. Tenisul de masa din Constanta este un izvor de talente care nu seaca niciodata. Ies la iveala noi si noi nestemate. A devenit o regula ca ...

Mihail Valentin Florescu a renuntat la mandatul de director general al firmei Upetrom 1 Mai Trading SRL, controlata de Gabriel Valentin Comanescu
www.ziuaconstanta.ro - Constanţa
In Monitorul Oficial al Romaniei a fost publicata hotararea Adunarii Generale a Asociatilor Upetrom 1 Mai Trading SRL. Astfel, Upetrom 1 Mai SA, in insolventa, detinatoare a 218.482 de parti ...

Caravana PNL. Vor continua seria seminarelor si dezbaterilor din care sa reiasa solutii si pentru Constanta
www.ziuaconstanta.ro - Constanţa
Caravana liberala , un proiect initiat de conducerea centrala a PNL, care vizeaza consolidarea cunostintelor teoretice ale membrilor, organizarea unor dezbateri in filiale cu simpatizantii liberali, dar ...

Imobil ridicat de Cambela Prod SRL pe soseaua Mangaliei, modificat. Va avea zece etaje in loc de opt
www.ziuaconstanta.ro - Constanţa
Societatea Cambela Prod SRL intentioneaza sa adauge doua etaje blocului de opt etaje pe care il ridica pe soseaua Mangaliei nr. 59A din municipiul Constanta. Primaria Constanta a emis, pe data de ...

Inspectorii de la Integritate, la judecata cu un fost primar din judetul Constanta
www.ziuaconstanta.ro - Constanţa
Agentia Nationala de Integritate l-a chemat in instanta pe Titu Neague, fostul primar al localitatii Baraganu. Conform portalului instantelor de judecata, in dosarul 3585 118 2018, ANI are ...

Primaria Constanta achizitioneaza insemne pentru marcarea si inscriptionarea adaposturilor de protectie civila din municipiu
www.ziuaconstanta.ro - Constanţa
Primaria Municipiului Constanta achizitioneaza prin procedura simplificata insemne pentru marcarea si inscriptionarea adaposturilor de protectie civila din municipiul Constanta. Este vorba despre ...

Lansarea volumului II al lucrarii Viata tacuta a naturii“ (1916-1946): Istoricul Ioan Opris - Doamna Doina Pauleanu este un bun de patrimoniu dobrogean, de-a dreptul!“ (galerie foto)
www.ziuaconstanta.ro - Constanţa
Una dintre cele mai proeminente figuri ale culturii de la malul marii - desi, de loc, se trage de la munte, din Brasov -, doctorul in istorie Doina Pauleanu a reusit sa adauge, dupa un adevarat ...

Porturile fluviale ale Dobrogei in perioada interbelica (anul de referinta 1931) (I) (galerie foto)
www.ziuaconstanta.ro - Constanţa
In anii 30 ai secolului XX, Regatul Romaniei Mari trecea printr-o infloritoare perioada de dezvoltare economica si industriala, fara precedent in istoria sa, si devenise unul din statele importante de ...

E brazilian“: Gica Hagi a marcat pentru Legendele Barcelonei in meciul cu Generatia de Aur a Romaniei (galerie foto)
www.ziuaconstanta.ro - Constanţa
Echipa Generatiei de Aur a Romaniei a sustinut, sambata, pe Cluj Arena, un meci demonstrativ contra Legendelor Barcelonei, eveniment inclus in cadrul Sports Festival. 25.000 de spectatori au aplaudat ...

Festivitate de sfarsit de an scolar: Primaria Cumpana a premiat elevii merituosi si sportivii de la echipa de fotbal juniori
www.ziuaconstanta.ro - Constanţa
Cantec, flori si bucurie! Acestea au fost vesmintele in care s-au imbracat elevii Liceului Tehnologic Nicolae Dumitrescu cu ocazia premierii celor mai merituosi elevi din localitatea Cumpana. Intr-o ...

Eveniment de lansare a platformei Web MOWEUP, la Ruse: CCINA Constanta si Camera de Comert si Industrie Dobrich, parteneri in proiect
www.ziuaconstanta.ro - Constanţa
Camera de Comert, Industrie, Navigatie si Agricultura Constanta CCINA are in implementare proiectul Promovarea mobilitatii fortei de munca in randul angajatilor si persoanelor inactive - Mobility ...

Accident mortal in Mamaia: Femeie spulberata pe o trecere de pietoni. Soferul, arestat preventiv la opt luni de la tragedie
www.ziuaconstanta.ro - Constanţa
Magistratii din cadrul Judecatoriei Constanta au decis mentinerea in arest preventiv a unui tanar de 27 de ani, din Cernavoda, care, in luna august 2017, ar fi accidentat mortal o femeie. Soferul ...

Sondaj de opinie: Credeti ca, luna viitoare, Simona Halep va castiga turneul de la Wimbledon?
www.ziuaconstanta.ro - Constanţa
Marea campioana Simona Halep si-a implinit inca un vis, impunandu-se in premiera, in urma cu noua zile, intr-un turneu de Grand Slam, la Roland Garros. Liderul clasamentului mondial a scapat de presiunea ...

Casa Soarelui“. Ce obligatii are Consiliul Judetean Constanta dupa publicarea HG in Monitorul Oficial. Urmatorul obiectiv trebuie sa fie redeschiderea sectiei de radioterapie!
www.ziuaconstanta.ro - Constanţa
Guvernul a trecut Casa Soarelui in domeniul public al Consiliului Judetean Constanta. Hotararea de Guvern privind actualizarea datelor de identificare si a valorii de inventar ale imobilului aflat in ...

Impresionanta“ participare... virtuala la montarea tutorilor pentru copacii tineri. 26 de participanti si 43 interesati pe Facebook, iar in realitate, doar… 13
www.ziuaconstanta.ro - Constanţa
Si de data aceasta Facebook-ul s-a dovedit mai fortos decat realitatea. In speranta ca va reusi sa convinga mai multi constanteni, avocatul Catalin Filisan, initiatorul unei adevarate campanii ...

#RespectTeatru #CitesteDobrogea #Thalia Ex Ponto. La cumpana de milenii: Seri de teatru antic
www.ziuaconstanta.ro - Constanţa
Adanca si miscatoare fantana, a carei taina se plateste in timp, este Dobrogea. Impresia de viata, in imateriale raspantii de timp, iti da orice loc de popas pe drumurile dobrogene... Pe ...

#RespectTeatru: Medalia Jean Ionescu“ si placheta CJC #RespectTeatru, pentru Anaid Tavitian
www.ziuaconstanta.ro - Constanţa
Evenimentul intitulat Incredibila memorie a teatrului constantean , organizat de cotidianul ZIUA de Constanta pe 12 iunie, in foaierul Teatrului National de Opera si Balet Oleg Danovski ca semn de ...

Achizitii multe la FC Viitorul. Vlad Achim a revenit la fosta campioana: Ne dorim sa jucam frumos si sa inscriem cat mai mult“ (galerie foto)
www.ziuaconstanta.ro - Constanţa
FC Viitorul, campioana Ligii 1 din sezonul 2016 2017, se afla la startul pregatirii pentru stagiunea 2018 2019 a intrecerilor interne si a Europa League. Formatia lui Gica Hagi a anuntat mai multe ...

Judetul Constanta, luat cu asalt de politicieni si demnitari. Unii au facut baie de multime, altii au reusit sa se faca din nou de ras. Premierul a fost huiduit!
www.ziuaconstanta.ro - Constanţa
Aglomeratie de politicieni si oficialitati pe litoral in weekendul care s-a incheiat. Black Sea and Balkans Security Forum 2018, Scoala de Vara a Tineretului Social-Democrat, Aeroportul de la Mihail ...

Revolta“ angajatilor din Serviciul Roman de Informatii: Nemultumirile au ajuns la urechile judecatorilor din Constanta
www.ziuaconstanta.ro - Constanţa
Mai multi angajati ai Serviciului Roman de Informatii au chemat la judecata institutia intr-un dosar ce are ca obiect drepturi banesti si materia litigii de munca . Dosarul a primit numarul ...

Accident rutier in zona ICIL din Constanta. Doua masini implicate
www.ziuaconstanta.ro - Constanţa
Un accident rutier s-a petrecut in aceasta seara in Constanta, in zona ICIL, la intersectia dintre bulevardele IC Bratianu si 1 Decembrie 1918. Au fost implicate doua masini, un Porsche si un ...

Stiati ca...?: Un cunoscut cantaret si compozitor englez implineste 76 de ani
www.ziuaconstanta.ro - Constanţa
Sir James Paul McCartney s-a nascut pe 18 iunie 1942 este un cantaret si compozitor englez, care s-a remarcat initial ca membru component al formatiei The Beatles. A scris si muzica de film, astfel ca ...

Sfecla rosie are efecte benefice in cazul problemelor digestive
www.ziuaconstanta.ro - Constanţa
Fiind alcatuita in proportie de 80 din fibre, sfecla rosie are efecte benefice in cazul problemelor digestive. Pentru cei cu stomac mai sensibil se recomanda ca ea sa fie consumata fiarta sau coapta, ...

#citesteDobrogea TOMI - CONSTANȚA monografie (1931). Capitolul IV. Stapanirea romaneasca: Regele Carol. Inteleptul si Dobrogea
www.ziuaconstanta.ro - Constanţa
Inceputurile stapanirii noastre in Dobrogia au fost foarte nesigure, timide, din cauza parerilor gresite, pe care le-au imprastiat oamenii nostri politici de pe atunci, care nu cunosteau nici starea ...

#RespectTeatru #Thalia Ex Ponto. La cumpana de milenii: Motivatie
www.ziuaconstanta.ro - Constanţa
Celor care vor avea bunavointa de a starui cateva ceasuri asupra acestei modeste scrieri suntem datoare sa le explicam de ce ea nu este o monografie in intelesul strict al notiunii. In primul rand ...

Autorizatie de construire pentru printul Șerban Dimitrie Sturdza, emisa de Primaria Municipiului Constanta
www.ziuaconstanta.ro - Constanţa
Consulul onorific al Republicii Macedonia, printul Serban Dimitrie Sturdza, continua investitiile la imobilul este situat pe strada Stefan cel Mare nr. 4. La aceasta adresa functioneaza Consulatul ...

Sondaj de opinie: Protest PSD la Bucuresti. Cei mai multi dintre participantii la sondaj considera ca mitingul nu trebuia organizat
www.ziuaconstanta.ro - Constanţa
La inceputul saptamanii trecute, dupa mitingul urias organizat de PSD la Bucuresti, am initiat o dezbatere si totodata un sondaj de opinie cu intrebarea Credeti ca era necesar protestul mamut ...

Sevda Impex SRL vrea sa extinda un spatiu comercial situat langa Cazinoul din Mamaia
www.ziuaconstanta.ro - Constanţa
Sevda Impex SRL se extinde in statiunea Mamaia. Firma pe care functioneaza un celebru magazin de bijuterii vrea sa extinda doua imobile, situate in Constanta, statiunea Mamaia. Astfel, firma Sevda ...

In memoria legendei FC Farul Dumitru Antonescu: Turneul de fotbal Junior Summer Cup“ debuteaza la Constanta
www.ziuaconstanta.ro - Constanţa
Prima editie a turneului de fotbal juvenil Junior Summer Cup debuteaza luni, 18 iunie, la Constanta. Intrecerea va fi gazduita de terenuri din complexul sportiv Farul str. Primaverii , participand ...

Atlet la LPS Nicolae Rotaru“ Constanta: Georgica Marian Turnea, campion national la juniori 2 (galerie foto)
www.ziuaconstanta.ro - Constanţa
Sapte medalii au obtinut atletii si atletele de la cluburi din judetul Constanta care au concurat la faza finala a Campionatului National de juniori 2, gazduita de stadionul Iolanda Balas Soter din ...

Incredibil cum a fost salvat omul legii!: Un politist din Constanta, muscat de degetul mijlociu al mainii stangi
www.ziuaconstanta.ro - Constanţa
Trimis in judecata de procurorii Parchetului de pe langa Judecatoria Constanta, prin rechizitoriul nr. 5162 P 2016, un barbat acuzat de ultraj si de tulburarea ordinii si linistii publice a fost ...

Havana Beach Trust SRL, unda verde de la Primaria Constanta. Firma va amenaja o plaja in Mamaia
www.ziuaconstanta.ro - Constanţa
Bogdan Rusinescu si Marian Alexandru, asociati in SC Havana Beach Trust SRL, vor amenaja un sector de plaja in Mamaia. Pe data de 15.06.2018, Primaria Constanta a emis Autorizatia de construire nr. 707, ...

Big Brother in comuna Mircea Voda. Comteh SRL se va ocupa de extinderea sistemului de supraveghere video stradala (document)
www.ziuaconstanta.ro - Constanţa
Comuna Mircea Voda a anuntat cu cine a semnat contractul Extindere sistem de supraveghere video stradala in comuna . Asa cum reiese din anuntul de atribuire, contractul in valoare de 133.094,08 lei a ...

Achizitie la Primaria Gradina. Trama stradala din comuna, reabilitata (document)
www.ziuaconstanta.ro - Constanţa
Trama stradala din comuna Gradina va fi reabilitata. In acest sens, Primaria Gradina anunta ca va organiza o procedura publica pentru atribuirea contractului Servicii de proiectare tehnica, ...

VIDEO CLUJ - Un poliţist l-a doborât la pământ şi i-a aplicat trei pumni la ficat. Vi se pare normal?
www.stiridecluj.ro - Cluj
VIDEO CLUJ - Un poliţist a doborât la pământ un bărbat şi i-a aplicat trei pumni la ficat

S-au împlinit 97 de ani de la primul meci de handbal din România. A fost la Sibiu
www.oradesibiu.ro - Sibiu
Zi importantă în istoria handbalului românesc. S-au împlinit 97 de ani de la primul meci jucat în ţara noastră. Se întâmpla la Sibiu în 1921. La 17 iunie 1921, se disputa primul meci de handbal din…

VIDEO – FOTO Cel mai tare party din zona Sibiului. Hayden a fost FABULOS
www.oradesibiu.ro - Sibiu
Avrig-ul a fost sâmbătă gazdă pentru un eveniment care se anunţă de aici încolo unul de top pentru iubitorii de muzică bună şi distracţie în aer liber. Aproape 1.500 de persoane au participat la…
![Neamţ: Accident filmat în direct. A traversat pe roşu şi a fost lovită de o maşină [VIDEO]](/showimg/300-200--zi/images/fullinfo.ro-images/news-186957.jpg)
Neamţ: Accident filmat în direct. A traversat pe roşu şi a fost lovită de o maşină [VIDEO]
www.stiri-neamt.ro - Neamţ
Neatenţie sau iresponsabilitate atunci când traversează, acestea sunt motivele din pricina cărora se întâmplă multe dintre accidentele din România. O

Întâmplare ȘOCANTĂ în judeţul Ialomiţa. O femeie a fost muşcată de un şarpe veninos
evz.ro - Bucureşti
O femeie din judeţul Ialomiţa a fost atacată şi muşcată de un şapte veninos. Victima a ajuns imediat la spital, unde a primit îngrijirile medicale necesare....

RĂZBOI DESCHIS la vârful lumii manelelor. Scandalul îl are în prim-plan pe Nicolae Guţă. „Să fiţi daţi de POMANĂ!”
evz.ro - Bucureşti
După apariţia cărţii care îl are în centru pe unul dintre cei mai cunoscuţi şi apreciaţi interpreţi de manele, Nicolae Guţă, un întreg scandal s-a iscat......

VIDEO – FOTO Cel mai tare party din zona Sibiului. Hayden a fost FABULOS
socialmedia.oradesibiu.ro - Sibiu
Avrig-ul a fost sâmbătă gazdă pentru un eveniment care se anunţă de aici încolo unul de top pentru iubitorii de muzică bună şi distracţie în aer liber. Aproape 1.500 de persoane au participat la…

Ce pensie are Petre Roman. Fostul premier încasează lunar venituri cât se poate de bune
www.stiridecluj.ro - Cluj
Ce pensie are Petre Roman. Fostul premier încasează lunar venituri cât se poate de bune

Românii din Diaspora au făcut plângere penală împotriva revistei ”Charlie Hebdo”
www.stiridecluj.ro - Cluj
Românii din Diaspora au făcut plângere penală împotriva revistei ”Charlie Hebdo”

Bianca Dragusanu şi Victor Slav s-au despărţit
www.stiridecluj.ro - Cluj
Bianca Dragusanu şi Victor Slav s-au despărţit

Noi avertizări meteo – Sibiul şi 17 judeţe sunt sub Cod Galben
www.oradesibiu.ro - Sibiu
ANM a anunţat duminică nou avertizări de vreme rea. Instabilitatea atmosferică o să se manifeste în aproape toată România. Administraţia Naţională de Meteorologie a emis o nouă avertizare Cod galben…

Brazilia nu a putut castiga nici ea la debutul la Campionatul Mondial. Condusa, Elvetia a revenit
www.ziuaconstanta.ro - Constanţa
In ultimul meci de astazi de la Campionatul Mondial de fotbal din Rusia, s-au intalnit, la Rostov, Brazilia si Elvetia, in grupa E, la debutul in competitie al celor doua echipe. Favorita la titlul ...

Surprize, surprize la Mondialul de fotbal: Brazilia nu izbuteşte să bată Elveţia, scor final 1-1
www.ziarulargesul.ro - Argeş
Brazilienii au început în forţă meciul şi, după primul sfert de oră, dădeau impresia că pot face ce vor cu mingea în faţa fundaşilor elveţieni. Selecao a marcat repede, în min. 20, după un şut superb al lui Coutinho. Se părea că vom asista la un simplu antrenament cu public al brazilienilor...

TRAFIC INFERNAL la intrarea în Capitală. Ploile BLOCHEAZĂ Bucureştiul. Coloana de maşini se întinde pe kilometri întregi
evz.ro - Bucureşti
Ploile creează haos la intrarea în Capitală, duminică seară. Traficul la punctele importante din afara Bucureştiului este aproape blocat, din cauza......

Cum arată cea mai sexy prezentatoare meteo din istorie - FOTO
www.stiridecluj.ro - Cluj
Yanet García, cea mai sexy prezentatoare meteo din istorie - FOTO

Noi avertizări meteo – Sibiul şi 17 judeţe sunt sub Cod Galben
socialmedia.oradesibiu.ro - Sibiu
ANM a anunţat duminică nou avertizări de vreme rea. Instabilitatea atmosferică o să se manifeste în aproape toată România. Administraţia Naţională de Meteorologie a emis o nouă avertizare Cod galben…

REVOCAREA Codruţei Kovesi. RĂSPUNSUL aşteptat de o ţară întreagă vine de la un judecător al CCR. Când trebuie să ACȚIONEZE Iohannis?
evz.ro - Bucureşti
Judecătorul CCR Petre Lăzăroiu, care a votat pentru decizia care îl obligă pe preşedintele Klaus Iohannis să o revoce pe şefa DNA, Laura Codruţa Kovesi......

Germania, UMILITĂ de Mexic în primul meci de la turneul final. Campioana mondială a debutat cu o înfrângere
evz.ro - Bucureşti
Germania, campioana mondială en titre, a pierdut surprinzător în faţa Mexicului, cu scorul de 1-0 (1-0), duminică, pe Stadionul Lujniki din Moscova, în Grup...

Mărturisirea-şoc a judecătorului CCR Lăzăroiu. Cum a decurs întânirea cu un consilier prezidenţial: „O ţară nu poate fi condusă de un ONG”
evz.ro - Bucureşti
Judecătorul CCR Petre Lăzăroiu a povestit, în direct la TV, cum s-a desfăşurat întâlnirea Simina Tănăsescu, consilier prezidenţial, în care i s-a spus că se...

Fotbal – CM 2018: Campioana mondiala Germania, invinsa de Mexic cu 1-0
ziarmm.ro - Maramureş
Campioana mondiala en titre, Germania, a fost invinsa surprinzator de selectionata Mexicului cu scorul de 1-0 (1-0), duminica, pe Stadionul Lujniki din Moscova, in Grupa F a Cupei Mondiale de fotbal d

Femeie, violată şi bătută crunt de un grup de bărbaţi. Ce a făcut pentru a fi sigură că agresorii vor fi pedepsiţi
evz.ro - Bucureşti
Vasilisa Komarov, o femeie din Marea Britanie care a fost violată de trei bărbaţi, a luptat pentru a-i face pe agresori să plătească pentru faptele lor....

Începe examenul de Bacalaureat 2018. Calendarul probelor. Ce trebuie să ştie toţi elevii şi părinţii?
evz.ro - Bucureşti
Bacalaureat 2018. Cea mai importantă probă şcolară pentru sute de mii de elevi se apropie cu paşi repezi. ne mai despart doar 8 zile de prima probă......

Atentie soferi. Este aglomeratie pe Autostrada Soarelui la intrare in Bucuresti. Coloana de masini este de aproximativ 2 km
www.ziuaconstanta.ro - Constanţa
Centrul INFOTRAFIC din Inspectoratul General al Politiei Romane informeaza ca pe Autostrada A2 Constanta - Bucuresti s-a format o coloana de vehicule de aproximativ 2 kilometri, care se deplaseaza cu ...

Post de conducere vacant la Primaria Mangalia. Cand este organizat concursul si ce conditii trebuie indeplinite
www.ziuaconstanta.ro - Constanţa
Primaria Municipiului Mangalia organizeaza concurs pentru ocuparea functiei publice de conducere vacant de director executiv - Directia Gospodarire Urbana si Servicii de Utilitati Publice. ...
![Aur pentru viitorul Reşiţei! Tinerele handbaliste de la Liceul „Traian Vuia“ sunt campioane naţionale! [FOTO/VIDEO]](/showimg/300-200--zi/images/fullinfo.ro-images/news-186936.jpg)
Aur pentru viitorul Reşiţei! Tinerele handbaliste de la Liceul „Traian Vuia“ sunt campioane naţionale! [FOTO/VIDEO]
expressdebanat.ro - Caraş-Severin
Antrenate de Lucia Moruţ, handbalistele de la Liceul Teoretic Traian Vuia din Reşiţa, Ariana Pascal, Denisa Rotaru, Ioana Danilescu, Rebeca Babuţiu, Roxana Voina, Lorena Scurtu, Alessia Diaconescu, Oana Tote, Slagiana Radosavlevici, Rut Spiridon, Flavia Tîmpa, Patricia Gavriluţa, Alexandra Urdei, Roxana Ilie, Rebeca Imbri şi Maria Danda, au câştigat titlul de campioane naţionale în competiţia junioarelor IV!

Mete-France avertizează: Urmează o vară fierbinte!
www.ebihoreanul.ro - Bihor
Această vară ar putea fi mai călduroasă decât ar fi normal pentru o mare parte din Europa şi bazinul mediteranean. Potrivit specialiştilor Meteo-France un front anticiclonic deja 'staţionat' în sud-estul continentului şi care, cel mai probabil, va persista, va face ca temperaturile să crească, iar cantităţile de precipitaţii să scadă.

Imagini SPECTACULOASE cu NATURA DEZLĂNȚUITĂ. Un tsunami a CĂZUT din CER - VIDEO
evz.ro - Bucureşti
Peter Maier, un alpinist celebru, a fost martorul unui fenomen rar în Austria. Un tsunami căzut din cer. Scena pe care el a filmat-o în zona lacului Millsta...

Cum s-ar putea RELANSA cariera politică a lui Dragnea. Ion Cristoiu DEZVĂLUIE adevărata MIZĂ din celebrul dosar. „Va fi AMÂNARE”
evz.ro - Bucureşti
Liderul PSD, Liviu Dragnea, aşteaptă sentinţa din dosarul angajărilor fictive de la DGASPC Teleorman. După ultima amânare, decizia ar putea fi dată pe 21 iu...

Accident grav. O femeie a fost strivita de o autoutilitara lovita de un autobuz stationat si care nu avea franele trase
www.ziuaconstanta.ro - Constanţa
O femeie in varsta de 44 de ani a fost transportata la Spitalul Sfantul Spiridon din Iasi dupa ce a fost strivita de un autoutilitara care a fost lovita la randul sau de un autobuz ce stationa la ...

Senzaţional! Râmnicu Vâlcea plin de culoare, veselie şi bucurie
ziaruldevalcea.ro - Vâlcea
Municipiul Râmnicu Vâlcea este începând de astăzi, gazda Festivalului Internaţional de Teatru “Ariel Inter Fest”. Primăria Municipiului Râmnicu Vâlcea şi Teatrul Municipal „Ariel” Râmnicu Vâ…

Germania, UMILITĂ de Mexic în primul meci de turneul final. Campioana mondială a debutat cu o înfrângere
evz.ro - Bucureşti
Germania, campioana mondială en titre, a pierdut surprinzător în faţa Mexicului, cu scorul de 1-0 (1-0), duminică, pe Stadionul Lujniki din Moscova, în Grup...

Regele Thailandei pune mâna pe o avere de 30 de miliarde de dolari
evz.ro - Bucureşti
Regele Vajiralongkorn a moştenit una dintre marile averi ale lumii, care, potrivit analiştilor, variază între 30 şi 60 de miliarde de dolari....

S-au împlinit 97 de ani de la primul meci de handbal din România. A fost la Sibiu
socialmedia.oradesibiu.ro - Sibiu
Zi importantă în istoria handbalului românesc. S-au împlinit 97 de ani de la primul meci jucat în ţara noastră. Se întâmpla la Sibiu în 1921. La 17 iunie 1921, se disputa primul meci de handbal din…

FOTO/ VIDEO: Trupa ”Bere Gratis” în concert la Alba Iulia, la Caravana Bergenbier EU SUNT 12
ziarulunirea.ro - Alba
Trupa ”Bere Gratis” a concertat la Alba Iulia, duminică, în cea de-a doua zi de desfăşurare a Caravanei Bergenbier EU SUNT 12. ”Revenim cu drag in Alba Iulia, de data aceasta in Caravana Bergenbier Eu sunt 12, acolo unde va asteptam si pe voi!”, au anunţat artiştii pe pagina de socializare. Concertul a început la […]

Primarul din Băbeni, Ştefan Bogdan, va amenaja locuri de joacă în Parcul Mare, în urma unei investiţii de 110.000 euro
ziaruldevalcea.ro - Vâlcea
La iniţiativa primarului oraşului Băbeni, Ştefan Bogdan, Consiliul Local Băbeni a aprobat luna trecută documentaţia tehnico-economică aferentă obiectivului de investiţii „Amenajare locuri de…

Sparle si soparle, 18.06.2018
ziaruldevalcea.ro - Vâlcea
„Victoria” fostului director al Oltchim, Constantin Roibu, împotriva administratorilor judiciari, în privinţa plăţii despăgubirilor de 500 milioane de euro este NEDEFINITIVĂ şi va fi atacată cu rec…

Bilanţul dezastrelor lăsate în urmă de ploile torenţiale căzute în ultimele zile în Vâlcea!
ziaruldevalcea.ro - Vâlcea
Urmare a situaţiilor aflate în dinamică, din cauza efectelor fenomenelor de instabilitate atmosferică accentuată, cantităţi de apă însemnate, manifestate prin averse torenţiale, frecvente de…

FOTO. Noul material din ,,Groapa lui Gyuszi” a început să cedeze! Lucrare de mântuială?
portalsm.ro - Satu Mare
Noul material din Groapa lui Gyuszi a început să cedeze! Lucrare de mântuială?

Trump CONTRAATACĂ. Avocatul preşedintelui cere MĂSURI împotriva procurorului care anchetează alegerile din 2016
evz.ro - Bucureşti
Rudy Giuliani, avocatul lui Donald Trump, este de părere că ancheta cu privire la o posibilă complicitate între Rusia şi echipa de campanie, ar trebui să fa...

Asistînd nepăsător la încălcarea Constituţiei de către Preşedinte, Parlamentul poate fi acuzat şi el de complicitate. România lui Cristoiu
evz.ro - Bucureşti
Istoria României ne oferă, sub semnul Istoria – marele prozator – întîmplarea cu premierul Dimitrie Sturdza, dus la Paris de Carol I pentru un consult de sp...

Bonurile fiscale emise in data de 5 mai 2018 au fost desemnate castigatoare la extragerea Loteriei bonurilor fiscale de duminica. Ce valoare trebuie sa aiba
www.ziuaconstanta.ro - Constanţa
Bonurile fiscale emise in data de 5 mai 2018, cu o valoare de 183 de lei, au fost desemnate castigatoare la extragerea Loteriei bonurilor fiscale de duminica, transmite Agerpres.ro La aceasta extragere ...

Pastorul olandez din Ocna Mureş arestat pentu viol în formă continuată a fost trimis în judecată
ziarulunirea.ro - Alba
Pastorul olandez din Ocna Mureş arestat pentu viol în formă continuată a fost trimis în judecată. Pastorul olandez care locuieşte la Ocna Mureş, arestat preventiv în 16 mai 2018 pentru agresiune sexuală asupra unui nepot al acestuia în vârstă de 5 ani, a fost trimis în judecată. Dosarul a fost înregistrat în 8 iunie, la […]

Festivalul „Virginia Zeani” pune Mureşul pe harta mondială a operei
www.zi-de-zi.ro - Mureş
Festivalul Internaţional de Operă ”Virginia Zeani ” debutează luni, 18 iunie la Târgu-Mureş, evenim

Primarul Gheorghe Dumbravă va realiza o strategie care să conducă la o dezvoltare durabilă a comunei Stoeneşti
ziaruldevalcea.ro - Vâlcea
Primarul comunei Stoeneşti, Gheorghe Dumbravă, este de părere că, în urma unei analize temeinice a potenţialului natural şi a necesităţilor sociale, se poate contura o strategie care să cond…

Young Boys şi Tiv All Stars, echipele târgoviştene care au terminat pe locul 3 şi 4 în Campionatul Regional de la Ploieşti!
www.gazetadambovitei.ro - Dâmboviţa
Târgoviştenii de la Young Boys, echipa de minifotbal patronată de Daniel Bălaşa şi antrenată de experimentatul Florin Anton, a terminat

Primarul din Băbeni, Ştefan Bogdan, va amenaja locuri de joacă în Parcul Mare, în urma unei investiţiii de 110.000 euro
ziaruldevalcea.ro - Vâlcea
La iniţiativa primarului oraşului Băbeni, Ştefan Bogdan, Consiliul Local Băbeni a aprobat luna trecută documentaţia tehnico-economică aferentă obiectivului de investiţii „Amenajare locuri de…

Bee-Zed: asteroidul emigrant interstelar
evz.ro - Bucureşti
Bee-Zed este un asteroid care orbiteaza in directie contrara planetelor din sistemul Solar, pe aceeasi orbita ca si planeta Jupiter. ...

O târgovişteancă este prima româncă învingătoare la „Olympia Amateur Spain”
www.gazetadambovitei.ro - Dâmboviţa
Târgovişteanca Andreea Căzăceanu a câştigat „Olympia Amateur Spain”, cel mai cunoscut concurs de fitness destinat amatorilor din întreaga lume. Andreea

O târgovişteancă este prima româncă învingătoarea la „Olympia Amateur Spain”
www.gazetadambovitei.ro - Dâmboviţa
Târgovişteanca Andreea Căzăceanu a câştigat „Olympia Amateur Spain”, cel mai cunoscut concurs de fitness destinat amatorilor din întreaga lume. Andreea

O târgovişteancă este prima româncă învingătoarea la „Olympia Amateur Spain”
www.gazetadambovitei.ro - Dâmboviţa
Târgovişteanca Andreea Căzăceanu a câştigat „Olympia Amateur Spain”, cel mai cunoscut concurs de fitness destinat amatorilor din întreaga lume. Andreea

De la NEATENȚIE la TRAGEDIE! O femeie din Iaşi a fost STRIVITĂ, din cauza unui ȘOFER de autobuz. A început ANCHETA!
evz.ro - Bucureşti
Un accident oribil s-a produs, duminică seară, în muncipiul Iaşi. O femeie a fost lovită grav de o autoutilitară. Se pare că totul s-a produs din cauza......

Flacăra HOREZU a obţinut scorul meciurilor tur ale barajului pentru promovarea în Liga 3! Vâlcea va avea din nou echipă la nivel naţional
ziaruldevalcea.ro - Vâlcea
FLACĂRA HOREZU – RAPID BUZESCU 8-0 16:33 VERDEŞ ŞI NISTOR AU REUŞIT ”DUBLE” Flacăra a obţinut scorul meciurilor tur ale barajului pentru promovarea în Liga 3! Vâlcea va avea din nou echipă la…

„Noaptea Sânzienelor” la Muzeul Etnografic „Anton Badea”
www.zi-de-zi.ro - Mureş
Municipiul Reghin şi Muzeul Etnografic „Anton Badea” organizează vineri, 22 iunie, evenimentul cultu

Carnagiu pe autostradă
glasul-hd.ro - Hunedoara
Tragedie, pe autostrada Deva-Simeria. Un şofer de 70 de ani, din Petroşani, a fost autorul cursei mortale. Potrivit poliţiştilor, şoferul intrase pe contrasens din nodul rutier de la Simeria Veche şi a mai circulat aproximativ trei kilometri spre Deva, pe banda a doua, până la impactul cu un microbuz. Bărbatul, dar şi alţi trei pasageri …

Reprezentanţii Universităţii Bucureşti reacţionează: Deva nu este primul oraş din România care are un master cu dublă diplomă
glasul-hd.ro - Hunedoara
În urma materialului publicat marţea trecută de „Glasul Hunedoarei”, care avea la bază declaraţiile făcute de prof. dr. Ion Radu, coordonatorul centrelor de învăţământ la distanţă ale ASE Bucureşti, conform cărora Deva ar fi primul oraş din România care va avea un program de master cu dublă diplomă, reprezentanţii Universităţii Bucureşti reacţionează. Aceştia susţin că …

COD GALBEN în Alba, duminică, până la ora 21.30 – Averse de ploaie, descărcări electrice şi grindină. Localităţile vizate
ziarulunirea.ro - Alba
O nouă avertizare cu cod galben a fost emisă de meteorologi, duminică, pentru judeţul Alba. Deocamdată este valabilă până la ora 21.30, dar există posibilitatea să fie prelungită. Sunt prognozate: Averse de ploaie care vor cumula 20-25 l/mp, descărcări electrice şi grindină de mici dimensiuni. Localităţile vizate sunt: Aiud, Blaj, Teiuş, Șona, Mihalţ, Lopadea Nouă, […]

Raţionament total ilogic. Ministrul Transporturilor spune că atunci când vom avea autostrăzi multinaţionalele vor pleca
glasul-hd.ro - Hunedoara
Se împlinesc 4 ani de când ar fi trebuit să circulăm pe o autostradă de la Nădlac măcar până la Sibiu. Multe şantiere sunt încă blocate. În aceste condiţii, ministrul Transporturilor, Lucian Şova, încearcă să „dreagă busuiocul”, venind cu o explicaţie care, dacă nu cumva e scoasă total din context, frizează ridicolul: în România, după …

100.000 de euro pentru fiecare tânăr fermier
glasul-hd.ro - Hunedoara
Este oficial! Tinerii fermieri din judeţul Hunedoara vor putea beneficia de un sprijin financiar dublu. Concret aceştia vor putea primi 100.000 de euro pentru instalarea ca şefi de exploataţie agricolă. Comisarul european pentru Agricultură, Phil Hogan, a prezentat, în data de 11 iunie 2018, în Parlamentul European, propunerea pentru noul regulament european după care va …

Basmul fotbalului, împărtăşit de Marian Nazat la Deva
glasul-hd.ro - Hunedoara
Biblioteca Judeţeană „Ovid Densusianu” Hunedoara-Deva a organizat în weekend un eveniment cultural care a atras un public extrem de numeros. A fost vorba despre lansarea cărţii „Basmul fotbalului născocit împreună cu Marius Mitran”, în două volume, a juristului şi publicistului Marian Nazat. Numele lui Marian Nazat, reputat avocat în cadrul Baroului Bucureşti, este familiar celor …

Artefacte de 400.000 de euro, recuperate de poliţiştii hunedoreni
glasul-hd.ro - Hunedoara
Mii de monede şi artefacte, obţinute de braconierii arheologici prin detecţii neautorizate în situri din judeţele Constanţa şi Tulcea, au fost descoperite şi confiscate de poliţişti hunedoreni împreună cu cei ai Direcţiei de Investigaţii Criminale, într-un dosar în care au colaborat autorităţile judiciare române şi cele germane. Valoarea bunurilor ridicate şi indisponibilizate se ridică la …

PLOAIA face RAVAGII în Capitală! INDUNDAȚIE într-o zonă extrem de aglomerată. Autorităţile intervin în forţă
evz.ro - Bucureşti
Ploaia care s-a aşternut, pentru o scurtă perioadă de timp, deasupra Capitalei nu a rămas fără repercusiuni. Aversele năprasnice au inundat mai multe......

LA SFAT CU PSIHIATRUL. Despre o tulburare psihică rară, care apare mai frecvent la bărbaţi: piromania
evz.ro - Bucureşti
Piromania este una dintre tulburările de control al impulsurilor şi se caracterizează prin nevoia/impulsul de a porni focuri, de a da foc diferitelor obiect...

Plachetă, în memoria comandantului
glasul-hd.ro - Hunedoara
Cazarma jandarmilor de la Lupeni se numeşte, de săptămâna trecută, Cazarma ,,col. (rz.) Jilip Petrişor – Toderiţă”. Aceasta îi va purta numele comandantului unităţii, decedat la sfârşitul lunii aprilie 2018. În memoria col. (rz.) Jilip Petrişor a fost dezvelită o placă comemorativă. Colonelul (rz.) Petrişor – Toderiţă Jilip s-a născut în data de 02.01.1956 în …

Dialogul orb al propriului adevăr
www.zi-de-zi.ro - Mureş
9 iunie 2018, ziua în care un sportiv a făcut ca o naţiune întreagă să simtă bucuria victoriei. Dar

Apel pentru salvarea unei nave militare abandonata in portul Mangalia. Canoniera Lt. Cdor. Eugen Stihi ar putea fi muzeu
www.ziuaconstanta.ro - Constanţa
Una dintre cele mai vechi nave militare romanesti a ajuns intr-o stare de degradare dupa ce a fost lasata sa rugineasca in portul Mangalia. In anul Centerarului se asteapta o Hotarare de Guvern pentru ...

HDR Tuning Show – costuri minime, beneficii mari
glasul-hd.ro - Hunedoara
Cu doar 5000 de lei şi o porţiune de stradă blocată pentru două zile, Primăria Hunedoarei a reuşit să creeze un eveniment din aproape nimic. O mare parte din merite le are însă Asociaţia „HD TunedClub” care a organizat, la finele săptămânii trecute, a treia ediţie a „HDR Tuning Show”. Ce-a de-a treia întâlnire a …

Daniel Băluţa: Primăria Vaideeni organizează în perioada 23-24 iunie ediţia jubiliară a Festivalului de folclor păstoresc „Învârtita Dorului”
ziaruldevalcea.ro - Vâlcea
Primăria comunei Vaideeni va organiza la sfârşitul acestei săptămâni, adică în perioada 23-24 iunie 2018, ediţia jubiliară a 50-a a Festivalului de folclor păstoresc „Învârtita Dorului”. Eve…

LIVE VIDEO: Trupa ”Bere Gratis” în concert la Alba Iulia. Caravana Bergenbier EU SUNT 12 se află în oraş
ziarulunirea.ro - Alba
Trupa ”Bere Gratis” concertează la Alba Iulia, duminică, în cea de-a doua zi de desfăşurare a Caravanei Bergenbier EU SUNT 12. ”Revenim cu drag in Alba Iulia, de data aceasta in Caravana Bergenbier Eu sunt 12, acolo unde va asteptam si pe voi!”, au anunţat artiştii pe pagina de socializare. Concertul a început la ora […]

Jiul a rupt un dig provizoriu
glasul-hd.ro - Hunedoara
Administraţia Parcului Natural Defileul Jiului anunţă că apele Jiului au rupt un dig temporar construit în zona Dumitra pentru o amenajare hidrotehnică. Un eveniment similar s-a petrecut în aceeaşi zonă cu o lună în urmă. „Jiul şi-a reluat cursul natural «spulberând» digul provizoriu de la şantierul Dumitra. Atenţie! Multe betoane şi obiecte periculoase în albie. …

Drumul spre Râuşor, redeschis în această săptămână
glasul-hd.ro - Hunedoara
Consiliul Judeţean şi Primăria comunei Râu de Mori au început încă de vineri lucrări pentru diminuarea stricăciunilor produse joi pe drumul de acces spre zona de agrement Râuşor. Primarul comunei, Niculiţă Mang, speră ca situaţia să revină la normal începând de miercuri. „Drumul este curăţat pe cei 7 kilometri de la Mănăstirea Colţ până în …

Distincţie importantă pentru un elev de la Arte la un concurs internaţional
glasul-hd.ro - Hunedoara
Elevii Liceului de Arte „Sigismund Toduţă” Deva au demonstrat că pot face performanţă şi la competiţii internaţionale. Astfel, la Concursul Internaţional de Interpretare Pianistică „Pro Piano –România”, elevul Mircea Vasile Logojan a obţinut premiul al II-lea. În perioada 11-16 iunie, la Bucureşti, a avut loc cea de-a XII-a ediţie a concursului internaţional. Concursul, organizat de …

Se deschide centrul multifuncţional din Nufărul, cu lecţii gratuite de germană pentru tineri şi ateliere pentru vârstnici
www.ebihoreanul.ro - Bihor
Direcţia de Asistenţă Socială Oradea va deschide, luni, după reabilitare, centrul multifuncţional al municipalităţii din cartierul Nufărul. În colaborare cu Asociaţia 'Rămâi Acasă' şi Asociaţia 'Pflege und Betreuung 24', DAS Oradea cheamă tinerii, vârstnicii şi persoanele cu dizabilităţi la tot felul de activităţi gratuite.

MORENI: Concurs cu biciclete pe traseu offroad. Taxa de participare va fi donată micuţului Antonio, diagnosticat cu cancer
www.gazetadambovitei.ro - Dâmboviţa
Tinerii din Moreni organizează pe 23 iunie, „THE HILLS HAVE WEELS”, un concurs cu biciclete pe traseu offroad. Concursul se

MORENI: Concurs cu biciclete pe traseu offroad. Taxa de participare va fi donată micuţelui Antonio, diagnosticat cu cancer
www.gazetadambovitei.ro - Dâmboviţa
Tinerii din Moreni organizează pe 23 iunie, „THE HILLS HAVE WEELS”, un concurs cu biciclete pe traseu offroad. Concursul se

Ilva Fest 2018, trei zile de artă în Munţii Călimani
www.zi-de-zi.ro - Mureş
Ilva Fest, Festivalul Artelor şi Prieteniei cum mai este el denumit, îşi va derula cea de a cincea

Alin Bonţa de devenit „premiant fără premiu”
glasul-hd.ro - Hunedoara
Cea de-a 140-a ediţie a manifestării „Premianţii fără premii” l-a avut, sâmbătă, ca protagonist pe Alin Bonţa, „un profesionist al tehnicii, pe care viaţa l-a dus înspre lumea cărţilor. Și apoi, printr-un alt concurs de împrejurări, în lumea ciclismului” spun organizatorii campaniei, după care în cea a reportajului scris (şi publicat de Glasul Hunedoarei în …

CS Hunedoara a cedat pe teren propriu în prima manşă a barajului pentru promovare
glasul-hd.ro - Hunedoara
Aşteptată cu mari speranţe la Hunedoara, partida de sâmbătă cu Voinţa Lupac din barajul interjudeţean de promovare în liga a treia nu a adus gazdelor victoria mult aşteptată, care să îi dea speranţe de calificare. Ba mai mult, oaspeţii s-au impus cu 1 – 0 după un joc pe care l-au controlat practic de la …

Glasul lui Ștefan CIOCAN
glasul-hd.ro - Hunedoara
(editorial publicat iniţial pe 8 noiembrie 2017) Călin Anton Popescu Tăriceanu are perfectă dreptate. Există un stat paralel. De fapt, există o Românie paralelă cu cea în care trăiesc ei, politicienii aflaţi la putere în România şi susţinătorii lor. Există o Românie în care oamenii trăiesc de pe o zi pe alta, muncind cinstit, educându-şi …

Din ce în ce mai puţini ROMÂNI. NATALITATEA a SCĂZUT DRAMATIC. Ce spun EXPERȚII?
evz.ro - Bucureşti
România se confruntă cu o problemă demografică severă. Natalitatea este la cel mai scăzut nivel din ultima jumătate de secol, pentru că mulţi tineri care......

Femeile sunt la putere: Deţin o treime din afacerile din România
ph-online.ro - Prahova
O treime din totalul afacerilor din România sunt conduse de femei. E o tendinţă în întreaga lume, potrivit unor studii recente. Cea mai mare provocare...

BOMBĂ în lumea mondenă: Bianca Drăguşanu şi Victor Slav s-au DESPĂRȚIT
ph-online.ro - Prahova
Bianca Drăguşanu şi Victor Slav s-au despărţit, lucru confirmat inclusiv de faptul că pe conturile personal de socializare nu au mai postat, de ceva t...

Surpriză şi nu prea: Mexic-Germania 1-0, în al doilea meci al zilei, la Mondialul din Rusia
www.ziarulargesul.ro - Argeş
Mexicul reuşit să producă surpriza, învingând Germania, scor 1-0, într-un meci încheiat cum câteva minute, la Campionatul Mondial de fotbal din Rusia. Jocul a fost unul tensionat, dârz disputat. Aşa cum a fost de aşteptat, mexicanii n-au venit ca mielul la tăiere la întâlnirea cu campionii...

Surpriza la Cupa Mondiala de Fotbal. Germania a fost invinsa de echipa de fotbal din Mexic in primul meci la Campionatul din Rusia
www.ziuaconstanta.ro - Constanţa
In grupa F a Mondialului din Rusia, Germania a debutat astazi cu infrangere impotriva Mexicului, pe Luzhniki Arena, din Moscova. Mexicanii s-au impus in fata nemtilor scor 1-0 si au reusit astfel o mare ...

Brand cunoscut în comerţul cu haine angajează la Târgu-Mureş!
www.zi-de-zi.ro - Mureş
Compania SecondTex angajează vânzător la un magazin nou de haine second hand din Târgu-Mureş. (Redac

Surpriza la Cupa Mondiala de Fotbal. Germania a fost invinsa de echipa de fotbal din Mexic in primul meci la Campioantul din Rusia
www.ziuaconstanta.ro - Constanţa
In grupa F a Mondialului din Rusia, Germania a debutat astazi cu infrangere impotriva Mexicului, pe Luzhniki Arena, din Moscova. Mexicanii s-au impus in fata nemtilor scor 1-0 si au reusit astfel o mare ...

Iulia Albu, pusă „LA COLŢ” de câştigătoare de la „Bravo, ai stil! All Stars”. Scandal între cele două „fashioniste”
evz.ro - Bucureşti
Pe parcursul sezonului patru de la

INFORMAȚII ULUITOARE. Ionela Prodan s-a iubit în SECRET cu un cunoscut CÂNTĂREȚ. Adevărul ȘOCANT s-a AFLAT abia ACUM
evz.ro - Bucureşti
Chiar dacă nici unul dintre ei nu mai este printre noi, mai multe voci susţin că între Ionela Prodan şi Ion Dolănescu a existat o relaţie amoroasă consumată...

Peisaje, comori naturale, muzee şi istoria lor. Motive de mândrie naţională
evz.ro - Bucureşti
Peisaje, comori naturale, muzee şi istoria lor. Motive de mândrie naţională...

Poliţiştii au ridicat droguri de mare risc de la domiciliul tinerei care a acidentat mortal un bărbat în Târgovişte
www.gazetadambovitei.ro - Dâmboviţa
Ancheta în cazul tinerei care a lovit mortal un bărbat pe trecerea de pietoni este preluată de DIICOT. Asta după

Polţiştii au ridicat droguri de mare risc de la domiciliul tinerei care a acidentat mortal un bărbat în Târgovişte
www.gazetadambovitei.ro - Dâmboviţa
Ancheta în cazul tinerei care a lovit mortal un bărbat pe trecerea de pietoni este preluată de DIICOT. Asta după

Fostul director al CET Govora, Mihai Balan, afla miercuri, 20 iunie, daca va merge 3 ani la inchisoare
ziaruldevalcea.ro - Vâlcea
Un complet de cinci judecători de la Înalta Curte de Casaţie şi Justiţie ar putea pronunţa, miercuri, 20 iunie, sentinţa definitivă în dosarul CET Govora, în care fostul senator Dan Şova a fost con…

FOTO, LIVE-TEXT, la Galtiu, Transalpina Șugag – Sportul Petreşti 2-2 (0-0),a restabilit egalitatea în minutul 90, în finala Cupei României, faza judeţeană | Trofeul, în premieră pentru finaliste
ziarulunirea.ro - Alba
Transalpina Șugag şi Sportul Petreşti, se înfruntă pentru câştigarea, în premieră a Cupei României, faza judeţeană. Trofeul reprezintă o miză însemnată pentru cele două grupări clasate pe podiumul Ligii a IV-a, după ce au visat etape bune la câştigarea campionatului. Finala este cuprinsă în programul zilei “sărbătorii fotbalului judeţean”, alături de festivitatea de premiere a […]

PIERDERE imensă pentru fotbalul din România! Un fundaş de fier a fost RĂPUS de CANCER!
evz.ro - Bucureşti
Fotbalul din ţara noastră mai pierde un nume greu. Totul s-a întâmplat din cauza cancerului, într-o formă foarte agresivă, la ficat, care l-a răpus pe......

„Matericul mănăstirilor vâlcene. O incursiune în spaţiul monahal feminin din mănăstirile vâlcene”
ziaruldevalcea.ro - Vâlcea
Cu binecuvântarea şi sub coordonarea Înaltpreasfinţitului Părinte Varsanufie, Arhiepiscopul Râmnicului, la Editura Praxis a apărut volumul Matericul mănăstirilor vâlcene. O incursiune în spaţiul mo…

Interventie dificila a pompierilor de la Descarcerare. Au carat sute de metri echipamentele necesare pentru a salva un barbat prins sub un motocultor
www.ziuaconstanta.ro - Constanţa
Un barbat in varsta de aproximativ 40 de ani si-a prins duminica piciorul stang intr-un motocultor, in timp ce executa niste lucrari pe un camp din apropierea comunei Cermei, el fiind transportat la ...

Voluntariat. 20 de orădeni au plantat flori în piaţa Ferdinand într-o acţiune de înfrumuseţare a oraşului (FOTO)
www.ebihoreanul.ro - Bihor
Circa 20 de orădeni de etnie maghiară, majoritatea în vârstă, au plantat duminică seară 300 de flori în jurul statuii dramaturgului Szigligeti Ede din Piaţa Ferdinand. Acţiunea de înfrumuseţare a oraşului a fost organizată în pregătirea galei de deschidere a festivalului Zilele Sfântului Ladislau care va avea loc luni seară la Teatrul Regina Maria. Participanţii vor să se unească într-o asociaţie care va avea ca scop înfrumuseţarea oraşului.

O nouă apariţie editorială: Pr. Dr. Ștefan Zară, „Sfântul Ambrozie al Mediolanului. Monografie patristică”
ziaruldevalcea.ro - Vâlcea
Numeroase studii de teologie românească vorbesc despre înnoirea Tradiţiei, reafirmând îndemnul întoarcerii la Părinţi, a traducerii operelor acestora, pentru regăsirea sensului viu şi valorilor spi…

Vino la munte şi descoperă reţeta de succes a unei tabere de neuitat şi a unui team building reuşit!
expressdebanat.ro - Caraş-Severin
La o altitudine de 650 de metri în staţiunea Crivaia, la 500 de metri de lacul Gozna şi 1 kilometru de pârtiile de schi, unde concentraţia de ozon este benefică, se ridică impozantă Cabana Claris, îmbărăcată acum cu haine noi. Prezentă şi activă de peste un deceniu, cabana este locul căutat de turişti din întreaga ţară pentru a-şi petrece vacanţele, sărbătorile şi momentele de neuitat din cadrul evenimentelor festive.

Incident ȘOCANT în Teleorman. Un tren a fost LOVIT de FULGER
evz.ro - Bucureşti
Furtuna şi ploile torenţiale din ultima vreme le-a dat emoţii călătorilor unui tren care circula prin judeţul Teleorman. Incidentul a avut loc în Vartoapele...

Cod portocaliu de inundatii pe raurile mici din judetele Tulcea si Constanta. Cand expira avertizarea hidrologilor
www.ziuaconstanta.ro - Constanţa
Institutul National de Hidrologie si Gospodarire a Apelor a emis in aceasta dupa-amiaza atentionari Cod portocaliu de inundatii pentru rauri mici din judetele Constanta si Tulcea, valabile pana la ...

Cod portocaliu de inundatii pe raurile mici din judetele Tulcea si Constanta. Ce spun hidrologii
www.ziuaconstanta.ro - Constanţa
Institutul National de Hidrologie si Gospodarire a Apelor a emis in aceasta dupa-amiaza atentionari Cod portocaliu de inundatii pentru rauri mici din judetele Constanta si Tulcea, valabile pana la ...

FOTO, LIVE-TEXT, la Galtiu, Transalpina Șugag – Sportul Petreşti 2-1 (0-0), Diaconu a înscris în finala Cupei României, faza judeţeană | Trofeul, în premieră pentru finaliste
ziarulunirea.ro - Alba
Astăzi, de la ora 18.00, pe Stadionul din Galtiu, două formaţii de pe Valea Sebeşului, Transalpina Șugag şi Sportul Petreşti, se înfruntă pentru câştigarea, în premieră a Cupei României, faza judeţeană. Trofeul reprezintă o miză însemnată pentru cele două grupări clasate pe podiumul Ligii a IV-a, după ce au visat etape bune la câştigarea campionatului. […]

Vine SFÂRȘITUL pentru Merkel? REVOLTĂ în interiorul partidului, în legătură cu tema MIGRAȚIEI. Cancelarul ar putea PLECA în câteva zile
evz.ro - Bucureşti
Cancelarul Germaniei, Angela Merkel, se află în faţa unei probe extrem de dificile. După ce iniţiativa de a forma o coaliţie de guvernare s-a prăbuşit......

Accident cu cinci victime în Neamţ. O maşină a ieşit în decor. Două dintre victime sunt copii
www.stiri-neamt.ro - Neamţ
Duminică, 17 iunie, în jurul orei 18:30, Dispeceratul Integrat ISU – Ambulanţă al judeţului Neamţ a fost anunţat, prin Sistemul naţional unic pentru

FOTO, LIVE-TEXT, la Galtiu, Transalpina Șugag – Sportul Petreşti 1-1 (0-0), Rahovean a egalat în finala Cupei României, faza judeţeană | Trofeul, în premieră pentru finaliste
ziarulunirea.ro - Alba
Astăzi, de la ora 18.00, pe Stadionul din Galtiu, două formaţii de pe Valea Sebeşului, Transalpina Șugag şi Sportul Petreşti, se înfruntă pentru câştigarea, în premieră a Cupei României, faza judeţeană. Trofeul reprezintă o miză însemnată pentru cele două grupări clasate pe podiumul Ligii a IV-a, după ce au visat etape bune la câştigarea campionatului. […]

Interventie dificila a pompierilor de la Descarcerare. Au carar sute de metri echipamentele necesare pentru a salva un barbat prins sub un motocultor
www.ziuaconstanta.ro - Constanţa
Un barbat in varsta de aproximativ 40 de ani si-a prins duminica piciorul stang intr-un motocultor, in timp ce executa niste lucrari pe un camp din apropierea comunei Cermei, el fiind transportat la ...

S-a DEZBRĂCAT special pentru Cupa Mondială. Un model brazilian a ÎNCINS planeta cu fotografiile din PLAYBOY - FOTO INCENDIAR
evz.ro - Bucureşti
Cea mai sexy suporteră a Braziliei, Suzy Cortez, străluceşte pe coperta celebrei reviste Playboy, într-un pictorial realizat special pentru Cupa Mondială ca...

Decizia care reaprinde SCANDALUL între Adriana Bahmuţeanu şi Silviu Prigoană
evz.ro - Bucureşti
Adriana Bahmuţeanu şi Silviu Prigoană au ajuns, din nou, în lumina reflectoarelor. După ce o perioadă au lăsat impresia că îşi văd de viaţă liniştiţi alătur...

FOTO, LIVE-TEXT, la Galtiu, Transalpina Șugag – Sportul Petreşti 0-1 (0-0), Afrapt a deschis scorul, finala Cupei României, faza judeţeană | Trofeul, în premieră pentru finaliste
ziarulunirea.ro - Alba
Astăzi, de la ora 18.00, pe Stadionul din Galtiu, două formaţii de pe Valea Sebeşului, Transalpina Șugag şi Sportul Petreşti, se înfruntă pentru câştigarea, în premieră a Cupei României, faza judeţeană. Trofeul reprezintă o miză însemnată pentru cele două grupări clasate pe podiumul Ligii a IV-a, după ce au visat etape bune la câştigarea campionatului. […]

Afaceri în creştere pentru Uzina Mecanică din Cugir, în anul 2017
ziarulunirea.ro - Alba
Cele două companii de stat din Cugir, cu obiect de activitate în domeniul fabricării armementului şi a muniţiei, au avut în 2017 activităţi profitabile. Împreună, cele două societăţi aflate în subordinea Ministerului Economiei au înregistrat o cifră de afaceri netă de circa 225 milioane lei (50 de milioane de euro) şi un profit net cifrat […]

ISTERIE în SUA. Ce a răspuns Kim Kardashian când a fost întrebată dacă vrea să devină PREȘEDINTELE ţării
evz.ro - Bucureşti
Un dialog purtat între Kim Kardashian şi realizatorul emisiunii The Van Jones Show, de pe CNN, arată că America e ţara tuturor posibilităţilor. Vedeta care...

BOMBA! Administratorul judiciar de la OLTCHIM, Gheorghe Piperea: Roibu are UN MILIARD de euro si trebuie sa ne plateasca DESPAGUBIRI!
ziaruldevalcea.ro - Vâlcea
„Victoria” fostului director al Oltchim, Constantin Roibu, împotriva administratorilor judiciari, în privinţa plăţii despăgubirilor de 500 milioane de euro este NEDEFINITIVĂ şi va fi atacată cu re…

FOTO, LIVE-TEXT, la Galtiu, Transalpina Șugag – Sportul Petreşti 0-0, la pauză, finala Cupei României, faza judeţeană | Trofeul, în premieră pentru finaliste
ziarulunirea.ro - Alba
Astăzi, de la ora 18.00, pe Stadionul din Galtiu, două formaţii de pe Valea Sebeşului, Transalpina Șugag şi Sportul Petreşti, se înfruntă pentru câştigarea, în premieră a Cupei României, faza judeţeană. Trofeul reprezintă o miză însemnată pentru cele două grupări clasate pe podiumul Ligii a IV-a, după ce au visat etape bune la câştigarea campionatului. […]

Fotbal – CM 2018: Costa Rica – Serbia 0-1
ziarmm.ro - Maramureş
Selectionata Serbiei a invins la limita reprezentativa Costa Ricai, cu scorul de 1-0 (0-0), duminica, pe Samara Arena, in Grupa E a Cupei Mondiale de fotbal din Rusia, informeaza AGERPRES. Serbia a ob

IPJ Maramures: Autospeciale noi in mediul rural
ziarmm.ro - Maramureş
Pentru cresterea capacitatii de actiune si al gradului de siguranta al cetatenilor, parcul auto al Inspectoratului de Politie al judetului Maramures s-a innoit din aceasta luna cu noua autospeciale ma

Ultima CUCERIRE a lui Cătălin Scărlătescu. Nimeni nu se AȘTEPTA la o asemenea IMAGINE… POZA cu ea a ajuns pe internet.
evz.ro - Bucureşti
Chef Cătălin Scărlătescu este unul dintre cei mai apreciaţi bucătari români şi, datorită acestui fapt, a strâns mii de fani în mediul online. Pentru cei......

Sabia crizei politice atarna asupra leului
ziarmm.ro - Maramureş
Evolutia raportului euro/leu a fost una stabila, insa aceasta se poate modifica oricand, in functie de schimarile care pot avea loc in mediul politic local. Saptamana a debutat cu o medie de 4,6586 le

Vizită la nivel înalt în România. Un oficial IMPORTANT american vine la Bucureşti. Se va discuta despre securitatea regională
evz.ro - Bucureşti
Wess Mitchell, adjunctul secretarului de stat american pentru Europa şi Eurasia, va sosi luni în vizită la Bucureşti, unde se va întâlni cu oficiali români ...

BOMBA! Administratorul judiciar Gheorghe Piperea de la OLTCHIM: Roibu are UN MILIARD de euro si trebuie sa ne plateasca DESPAGUBIRI!
ziaruldevalcea.ro - Vâlcea
„Victoria” fostului director al Oltchim, Constantin Roibu, împotriva administratorilor judiciari, în privinţa plăţii despăgubirilor de 500 milioane de euro este NEDEFINITIVĂ şi va fi atacată cu re…

Accident grav la Tatarani. Doua masini s-au lovit frontal, o victima
ph-online.ro - Prahova

Imagini de la eveniment. Accident rutier pe DN22 in zona Sibioara. O masina s-a rasturnat. Doua persoane au fost ranite
www.ziuaconstanta.ro - Constanţa
Un accident rutier a avut loc in aceasta dupa amiaza pe DN22 Constanta Tulcea, in intersectia de la Sibioara. Din primele informatii doua persoane au fost ranite dupa ce masina in care se aflau ...

Românii din Occident dau în judecată publicaţia Charlie Hebdo
www.desteptarea.ro - Bacău
Federaţia Asociaţiilor de Români din Europa – FADERE, din care fac parte sute de băcăuani, deschide luni, 18 iunie, cu sprijinul Casei de avocatură „Paredes y Asociados”, un proces împotriva publicaţiei franceze „Charlie Hebdo” pentru caricatura prin care o ironizează pe tenismena Simona Halep şi pe români în general. Imediat după ce a câştigat turneul …

Pompierii bihoreni, victorioşi la Campionatul de Atletism şi Cros al MAI (FOTO)
www.ebihoreanul.ro - Bihor
Pompierii militari bihoreni s-au clasat pe primele locuri la diferite probe sportive, în cadrul etapei finale a Campionatului de Atletism şi Cros al Ministerului Afacerilor Interne. Ei s-au întors acasă cu două medalii de aur, una de argint şi două menţiuni.

Informare meteo. In cea mai mare parte a tarii, vor fi perioade cu instabilitate atmosferica accentuata
www.ziuaconstanta.ro - Constanţa
Meteorologii au emis o informare meteo valabila in intervalul 17 iunie, ora 15.00 18 iunie, ora 21.00, cand vor fi perioade scurte de timp cu instabilitate atmosferica accentuata Potrivit ANM, in ...

Anunţ HALUCINANT! Cercetătorii au găsit o SOLUȚIE să readucă la viaţă DINOZAURII. Descoperirea făcută oferă SPERANȚE
evz.ro - Bucureşti
Recent, specialiştii au reuşit să identifice structura genomică a dinozaurilor. Această structură este reprezentată de modul în care genele sunt aranjate pe...

Greşeală de protocol în prezenţa lui Dăncilă. REACȚIE DIPLOMATICĂ, după GAFA de la Constanţa. „Aruncă o UMBRĂ URÂTĂ asupra evenimentului”
evz.ro - Bucureşti
Premierul Viorica Dăncilă a fost prezent la inaugurarea consulatului Estoniei în România, iar ceremonia a fost marcată de o greşeală de protocol care a ajun...

Trei situri mureşene, incluse în Programul Naţional Limes
www.zi-de-zi.ro - Mureş
În prezent, în România se află în derulare un program care are ca obiectiv derularea de activităţi ş

Cine este pompierul-erou care a intervenit la incendiul ce a cuprins o rulota campata in Mamaia Nord. Pompierul de la ISU Delta era in vacanta (galerie foto-video)
www.ziuaconstanta.ro - Constanţa
O rulota campata in Mamaia Nord a fost cuprinsa ieri dupa amiaza de flacari si a explodat in Mamaia Nord. Un pompier aflat in concediu in acelasi camping a actionat de urgenta pana la sosirea ...

Cine este pompierul-erou care a intervenit la incendiul ce a cuprins o rulota campata in Mamaia Nord. Pompierul de la ISU Delta era in vacanta
www.ziuaconstanta.ro - Constanţa
O rulota campata in Mamaia Nord a fost cuprinsa ieri dupa amiaza de flacari si a explodat in Mamaia Nord. Un pompier aflat in concediu in acelasi camping a actionat de urgenta pana la sosirea ...

Alcoolul, mai important decât viaţa?!
expressdebanat.ro - Caraş-Severin
Băut bine, potrivit martorilor, un bărbat de 42 de ani din Moldova Nouă şi-a riscat viaţa astăzi, urcându-se la volan. Cu simţurile anesteziate de alcool, omul a ajuns cu maşina în şanţ.

VIDEO: Ghiţă, ”vedeta” oraşului, surprins din nou la plimbare, printre maşini. Albaiulienii sunt cu ochii pe el şi pe autorităţile care ar trebui să rezolve situaţia
ziarulunirea.ro - Alba
Duminică, Ghiţă, ”vedeta” oraşului Alba Iulia, a fost surprins din nou în imagini, plimbându-se pe mijlocul drumului, printre maşini. Situaţia a fost prezentată de atâtea ori în ultima vreme, încât nu mai are nevoie de nicio descriere. Putem însă concluziona: albaiulienii sunt cu ochii pe porcul Ghiţă, dar şi pe autorităţile care par să nu […]

Ce i s-a ÎNTÂMPLAT lui Hanibal Dumitraşcu după MOARTE. Familia este în STARE de ȘOC. Nimeni NU a crezut că e POSIBIL
evz.ro - Bucureşti
Hanibal Dumitraşcu a fost dat în judecată, din cauza unui credit pe care îl făcuse în 2013, la 18 zile după ce a părăsit această lume. ...

Detaliile ASCUNSE ale căsniciei lui Ilie Năstase cu Brigitte. Ani de DRAMĂ! „M-am pus în genunchi… Am SUFERIT!”
evz.ro - Bucureşti
Aflată în plin proces de divorţ, Birgitte Năstase, soţia fostului mare tensimen Ilie Năstase, nu s-a mai putut abţine. Amintirile au năpădit-o şi a spus......

Viorica Dăncilă a uitat cum îl cheamă pe premierul Estoniei, invitat oficial în România - VIDEO
www.stiridecluj.ro - Cluj
Viorica Dăncilă a uitat cum îl cheamă pe premierul Estoniei, invitat oficial în România - VIDEO

Steagul Estoniei, montat invers la întâlnirea cu Dăncilă. Premierul Estoniei a reparat gafa - VIDEO
www.stiridecluj.ro - Cluj
Steagul Estoniei, montat invers la întâlnirea cu Dăncilă. Premierul Estoniei a reparat gafa - VIDEO

Dreptate pentru o TÂNĂRĂ din Târgu Jiu! Un medic a fost CONDAMNAT definitiv pentru MALPRAXIS. Cazul care a ȘOCAT România
evz.ro - Bucureşti
Un medic ORL din Târgu Jiu a fost condamnat definitiv de Curtea de Apel Craiova la trei ani de închisoare cu suspendare, pentru că o tânără a murit. ...

SCANDAL cu BÂTE şi SĂBII în CENTRUL oraşului. Jandarmii au rămas ȘOCAȚI
evz.ro - Bucureşti
Un târg auto din Focşani a fost centrul unei altercaţii între şase tineri. Nu o altercaţie verbală, ci una în care s-au folosit săbii, notează presa locală....

Perchezitii in judetul Constanta la suspecti de contrabanda cu tigari. Ce au descoperit politistii in urma descinderilor
www.ziuaconstanta.ro - Constanţa
In urma actiunilor desfasurate, in ultima saptamana, pentru siguranta transporturilor aeriene, navale si feroviare, politistii au depistat 13 persoane date in urmarire nationala, au intocmit 85 de ...

Investiţii finalizate la şcolile din Mihăeşti
www.ziarulargesul.ro - Argeş
Începând din toamna acestui an, peste 750 de elevi de la Mihăeşti vor învăţa în condiţii civilizate, primăria şi Consiliul Judeţean Argeş finalizând reabilitarea şi modernizarea unităţilor de învăţământ, inclusiv construirea grupurilor sanitare în interiorul şcolilor. La sfârşitul săptămânii s-a...

Atac armat la un festival din New Jersey. Aproximativ 1.000 de persoane participau la eveniment. O persoana a murit
www.ziuaconstanta.ro - Constanţa
Un atac armat a avut loc in New Jersey unde aproximativ 1000 de persoane participau la un festival. Cel putin o persoana si-a pierdut viata si alte 20 au fost ranite. Potrivit Antena3.ro, un individ a ...

CS Pristavu, la un pas de titlu
www.ziarulargesul.ro - Argeş
În weekend a avut loc mult aşteptata finală a Superligii Naţionale la tenis de masă. Şi anul acesta, în ultimul act s-au confruntat cele două echipe argeşene, CS Mioveni şi CS Pristavu Câmpulung, cele mai titrate din ţară în acest moment. Vineri, la Câmpulung, CS Pristavu s-a impus, cu 5-2, în...

Unirea Bascov a câştigat manşa tur a barajului
www.ziarulargesul.ro - Argeş
Sâmbătă, stadionul din Mioveni a găzduit manşa tur a barajului de promovare în liga a treia, dintre formaţiile Unirea Bascov şi Vediţa Coloneşti. A fost un meci în care s-au duelat doi vechi buni prieteni şi foşti colegi, Adrian Dulcea - antrenor al celor de la Unirea Bascov, şi Mircea Stan...

Vom avea referendum pe tema justiţiei?
expressdebanat.ro - Caraş-Severin
Explicând că n-a înţeles încă motivarea deciziei CCR privind revocarea şefei DNA, preşedintele Iohannis a propus o „dezbatere largă” care să se încheie eventual cu un referendum. Ce întrebări ar urma să pună un asemenea referendum, pe care preşedintele îl avea oricum în vedere încă de anul trecut? Posibile răspunsuri, într-o analiză făcută azi de Mediafax.

Antrenor nou la BCM U Piteşti
www.ziarulargesul.ro - Argeş
Pentru echipa de baschet a Piteştiului, sezonul 2017-2018 nu a fost unul prea reuşit. Din acest motiv, conducerea clubului caută să reclădească echipa din temelii, iar primul pas îl reprezintă antrenorul. Conform site-ului total baschet.ro, favorit să preia trupa din Trivale este un alt...

Limba noastră-i o comoară… şi în Ucraina!
www.ziarulargesul.ro - Argeş
Şcoala "Tudor Vladimirescu" din Piteşti (director Nicoleta Biţa, dir. adjunct Magdalena Crivac), în parteneriat cu ISJ Argeş şi Asociaţia Cadrelor Didactice de Etnie Română din Ucraina (ACDERU), preşedinte Lilia Govornean, a iniţiat proiectul educaţional transfrontalier "Limba noastră-i o...

Ce fată SEDUCĂTOARE are Marius Șumudică. Sarah a UIMIT cu imaginile INCENDIARE în costum de baie - Galerie FOTO HOT
evz.ro - Bucureşti
Sarah, fiica celebrului antrenor Marius Șumudică, a uimit pe toată lumea după ce s-a fotografiat provocator la piscină, în costum de baie. ...

LOVITURĂ STRATEGICĂ în Coreea. Trump şi Moon au CEDAT în faţa lui Kim? Urmează ordinul pentru soldaţi
evz.ro - Bucureşti
Cutremur în una dintre cele mai tensionate zone ale planetei. Coreea de Sud şi Statele Unite vor anunţa suspendarea exerciţiilor militare la scară largă......

CAMPIONATUL MONDIAL. „Bomba” lui Kolarov a salvat Serbia de o remiză cu naţionala din Costa Rica
evz.ro - Bucureşti
Costa Rica - Serbia, primul meci al Grupei E a Mondialului din Rusia, s-a încheiat astăzi cu victoria europenilor, scor 1-0....

Sute de motive ce susţin mândria de a fi român la aniversare centenară
evz.ro - Bucureşti
Sute de motive ce susţin mândria de a fi român la aniversare centenară...

EFECTELE GLOBALE ale tranzacţiei de 22 de MILIARDE euro
evz.ro - Bucureşti
Despărţirea dintre Facebook şi cei doi fondatori ai WhatsApp după cea mai mare tranzacţie făcută de platforma de socializare, s-a soldat cu un scandal imen...

Operaţii laparoscopice, la Clinica de Urologie din Târgu-Mureş
www.zi-de-zi.ro - Mureş
După aproape două decenii de la adoptarea operaţiilor laparoscopice în România, Clinica de Urologie

O stewardesă din Târgovişte a câştigat cel mai tare concurs de fitness din lume. Vezi cum arată! (FOTO)
www.ebihoreanul.ro - Bihor
Andrea Căzăceanu, o stewardesă din Târgovişte stabilită în Dubai, a câştigat concursul „Olympia Amateur Spain”, una dintre cele mai tari competiţii destinate amatorilor din lume. Românca a câştigat medalia de aur şi cardul care îi dă dreptul de a participa la concursurile pentru profesionişti. Sportiva de 31 de ani este la a doua performanţă notabilă.

FOTO: Sărbătoarea fotbalului judeţean 2018 şi festivitate de premiere, la Galtiu! Vezi laureatele şi golgheterii competiţiilor organizate de AJF Alba
ziarulunirea.ro - Alba
În acest an la Galtiu, festivitatea de premiere a competiţiilor fotbalului amator din judeţ, prevăzută, înaintea finalei Cupei României, faza judeţeană, dintre Transalpina Șugag şi Sportul Petreşti (ora 18.00), pune punct stagiunii 2017-2018 în Alba, într-un mod spectaculos. O manifestare de apreciat a Asociaţiei Judeţene de Fotbal Alba, devenită deja tradiţie, „Sărbătoarea fotbalului judeţean” recompensează […]

FOTO/VIDEO – Flamenco, tobe, culorile Columbiei, Bolero pe ritmuri tribale şi bunicuţe dansatoare ieri la FITS!
www.oradesibiu.ro - Sibiu
Flamenco este un dans care cucereşte şi impresionează publicul sibian an de an la FITS! Spectacolul văzut ieri, Sânge şi lumină, al “De Sangre y Raza” Flamenco Ballet, în coregrafia lui Juan Manuel…

FOTO – Accident la Copşa Mică. Intervine SMURD-ul
www.oradesibiu.ro - Sibiu
Traficul rutier pe DN14 este afectat duminică între Mediaş şi Sibiu din cauza unui accident rutier petrecut la Copşa Mică (ora 15.55). Este vorba de o tamponare din care a rezultat rănirea a două…

FOTOGALERIE. Sediu nou pentru Primăria din Band!
www.zi-de-zi.ro - Mureş
Conducerea Primăriei comunei Band a inaugurat vineri, 15 iunie, într-un cadru ceremonios, noul sediu

ATAC ARMAT la un FESTIVAL din SUA! Peste 20 de VICTIME, printre care un MORT. „Iadul s-a dezlănţuit!”
evz.ro - Bucureşti
Stare de alertă în SUA, după ce 20 de persoane, inclusiv un adolescent, au fost rănite în primele ore ale zilei de duminică, într-un atac armat la un......

Boală din sec. XVIII, contractată de un tânăr. Simptomele
evz.ro - Bucureşti
Boală din sec. XVIII, contractată de un tânăr. Simptomele...

Istanbulul, oraşul ce TREBUIE vizitat! Din Cluj e chiar uşor, fiind un zbor direct cu Turkish Airlines
www.stiridecluj.ro - Cluj
Istanbulul este oraşul ideal pentru o escapadă de câteva zile, av&am...

NEWS ALERT/ Un bărbat şi-a PRINS un PICIOR la MOTOCULTOR! A fost preluat de ELICOPTERUL SMURD
newsar.ro - Arad
Citeşte azi ce scriu ziarele de mâine!

Accident rutier pe DN14. Traficul in zona a fost blocat. Doua persoane au fost ranite
www.ziuaconstanta.ro - Constanţa
Doua persoane au fost ranite intr-un accident rutier produs duminica pe DN14, la iesirea din Copsa Mica spre Medias, unde traficul rutier este blocat, a anuntat purtatorul de cuvant al Inspectoratului ...

Satul din Alba care a răzbit în istorie prin hărnicia şi dragostea de pământ a locuitorilor săi
ziarulunirea.ro - Alba
Dealuri blânde, cu păşuni mănoase, munţi semeţi, de o frumuseţe dumnezeiască, o dragoste eternă pentru pământ (pentru ”soartea” cu care le-au fost împroprietăriţi strămoşii, după 1921), netrădată de arginţi, cum s-a întâmplat prin alte părţi, toate au făcut din satul Purcăreţi, comuna Pianu, una dintre cele mai bine văzute comunităţi de crescători de animale din […]

IONEȘTI: Pompierii caută un bărbat dispărut la scăldat
www.gazetadambovitei.ro - Dâmboviţa
Pompierii detaşamentului Găeşti intervin pentru găsirea unui bărbat în vârstă de 64 de ani, despre care se presupune că s-a

FOTO: Accident rutier: O maşină condusă de tânăr în vârstă de 19 ani, din Alba, lovită de un autoturism, la Copşa Mică
ziarulunirea.ro - Alba
Un autoturism condus de un şofer de 19 ani, din Alba Iulia, a fost implicat într-un accident rutier produs pe DN 14, la ieşire din Copşa Mică spre Mediaş. Potrivit IPJ Sibiu, un sofer de 61 de ani, din Medias, in timp ce conducea autoturismul dinspre Sibiu, pe fondul neatentiei in conducere, a patruns pe […]

De pe băncile şcolii, direct în şomaj!
www.ziarulargesul.ro - Argeş
Din cauza lipsei unei reale îndrumări în timpul cursurilor, dar şi pentru că "le put" profesionalele şi liceele unde pot învăţa o meserie căutată pe piaţa muncii, mulţi elevi ajung direct în şomaj după absolvire. Şi când te gândeşti că tot mai multe firme caută forţă de muncă, iar uneori o aduc...

MĂCEL în SUA! Cel puţin 20 de VICTIME, în urma unui ATAC ARMAT la un FESTIVAL. „IADUL s-a DEZLĂNȚUIT”
evz.ro - Bucureşti
Stare de alertă în SUA, după ce 20 de persoane, inclusiv un adolescent, au fost rănite în primele ore ale zilei de duminică, într-un atac armat la un......

Marin Sorescu - unul dintre motivele mândriei mele de a fi român
evz.ro - Bucureşti
Marin Sorescu - unul dintre motivele mândriei mele de a fi român...

Prima REACȚIE a Biancăi Draguşanu după DESPĂRȚIREA de Victor Slav. Fanii au rămas ȘOCAȚI. Nu le-a venit să CREADĂ OCHILOR
evz.ro - Bucureşti
Bianca Drăguşanu şi Victor Slav s-au despărţit din nou. După separare, a plecat pe litoral, unde s-a distrat aşa cum a ştiut mai bine....

Aceasta este situaţia salarială la Spitalul Judeţean Argeş!
www.ziarulargesul.ro - Argeş
După protestul spontan de la Spitalul Judeţean Argeş de miercurea trecută, care se pare că a fost generat de la o eroare de soft, vineri la Consiliul Judeţean, a fost organizată o conferinţă de presă. Au participat Ion Mânzână, vicepreşedinte al CJ Argeş, Adriana Molfea, manager interimar al...

Dezvăluiri IREALE despre CENZURA magistraţilor: „Nu e frumos să laşi mii de magistraţi în aer pentru a proteja imaginea unuia”
evz.ro - Bucureşti
Închiderea grupului de yahoo Magistratro, de către judecătorul Cristi Danileţ a stârnit indignare în rândul magistraţilor. Motivul? În acest spaţiu virtual ...

Tânăr băut şi fără permis, prins de poliţişti după o urmărire de aproape un kilometru
feeds.monitorulsv.ro - Suceava
Ultima ora: Un individ in varsta de numai 23 de ani s-a ales cu dosar penal dupa ce a fost prins de politisti dupa o urmarire aproape ca-n filme. Sambata seara, in jurul orei 21.45, politistii Sectiei 14 Politie Rurala Vama au incercat sa opreasca in trafic, pe drumul judetean 176, un autovehicul marca Opel Corsa, care circula dinspre Vatra Moldovitei spre satul Argel.

Constanta. Trei nave sunt avizate pentru sosire in porturile maritime romanesti. Sub ce pavilion sunt
www.ziuaconstanta.ro - Constanţa
Conform listei navelor avizate pentru sosire in data de 17 iunie 2018 in porturile maritime romanesti, publicate de portalul Compania Nationala Administratia Porturilor Maritime Constanta, sunt avizate 3 ...

PRĂPĂD în Arad: Străzi INUNDATE, copaci DOBORÂŢI! Intervine Inspectoratul pentru Situaţii de Urgenţă
newsar.ro - Arad
Citeşte azi ce scriu ziarele de mâine!

DOLIU pentru familia REGALĂ. Soţia PRINȚULUI a MURIT după un ACCIDENT GRAV
evz.ro - Bucureşti
Prinţul Cambodgiei a fost implicat într-un accident rutier în provincial Preah Sihanouk, anunţă agenţiile de ştiri din întreaga lume....

FOTO – Accident la Copşa Mică. Intervine SMURD-ul
socialmedia.oradesibiu.ro - Sibiu
Traficul rutier pe DN14 este afectat duminică între Mediaş şi Sibiu din cauza unui accident rutier petrecut la Copşa Mică (ora 15.55). Este vorba de o tamponare din care a rezultat rănirea a două…

O micuţă de doar 8 ani din Neamţ i-a luat la„roast” pe juraţii NextStar. Video VIRAL!
www.stiri-neamt.ro - Neamţ
Sara Șmighelschi, elevă la cursul de teatru din clubul Viva Allegria Piatra-Neamţ a participat sâmbătă, 16 iunie, la prima editie din acest sezon (sezonul

FOTO: „Programul Talent”, pepinieră a handbalului masculin românesc
www.zi-de-zi.ro - Mureş
Municipiul Târgu-Mureş a găzduit, în perioada 15-17 iunie, Turneul Final al proiectului „Programul T

VREMEA. Se anunţă PRĂPĂD în toată ȚARA! 18 judeţe sub incidenţa CODULUI GALBEN. ANM: 40-50 l/mp!
evz.ro - Bucureşti
Vremea continuă să cunoască fluctuaţii majore. Administraţia Naţională de Meteorologie (ANM) a emis, duminică, o atenţionare meteorologică cod galben de plo...

Kirchweih la Palota: Micuţa comunitate de germani şi-a sărbătorit întemeietorul şi protectorul spiritual (FOTO/VIDEO)
www.ebihoreanul.ro - Bihor
Gătiţi de sărbătoare şi într-o odine fără cusur, cei aproximativ 250 de şvabi din Palota au colindat duminică dimineaţă, cu mic, cu mare, toate uliţele satului, continuând o tradiţie veche de aproape două secole – Kirchweih. Prin parada cu dansuri, participarea la o slujbă religioasă specială şi petrecerea de după, cea mai compactă comunitate de germani din Bihor şi-a sărbătorit atât întemeietorul, pe contele Johann Maria Frimont, cât şi patronul spiritual, pe Sfântul Anton de Padova.

A fost deschis Consulatul Onorific al Republicii Estonia la Constanta. Cateva informatii despre Republica Estonia
www.ziuaconstanta.ro - Constanţa
Premierul Viorica Dancila a participat astazi de la ora 11.00, alaturi de prim-ministrul eston J ri Ratas, la inaugurarea Consulatului Onorific al Republicii Estonia la Constanta. La eveniment au mai ...

Tăriceanu, atac dur la adresa conducerii PNL: „Poziţionare ruşinoasă”
evz.ro - Bucureşti
Călin Popescu Tăriceanu, liderul ALDE, a făcut o analiză dură a situaţiei actuale în care se află PNL, partidul care „a scris cea mai frumoasă parte a istor...

FRANȚA, SUB TEROARE. Un nou ATAC TERORIST ȘOCHEAZĂ întreaga ţară. MARTORII au văzut NEGRU în faţa ochilor
evz.ro - Bucureşti
Un noua tac terorist pătează o zi de duminică liniştită din Franţa. O femeie a rănit două persoane dintr-un supermarket în timp ce striga „Allah Akbar”....

FITS 2018 ajunge la final – Spectacole de top în ultima zi a ediţiei aniversare
www.oradesibiu.ro - Sibiu
Gala Celebrităţilor din data de 16 iunie a fost prilejul revederii publicului FITS cu Mikhail Baryshnikov şi toţi ceilalţi artişti care au primit o stea pe Aleea Celebrităţilor din 2018: Isabelle…

FOTO: Juniorul Aiud a câştigat Campionatul Speranţelor „Dragoş Damian”! Echipa lui Cristi Biro , învingătoare în premieră în competiţia juvenilă
ziarulunirea.ro - Alba
Astăzi, în cadrul Sărbătorii Fotbalului Judeţean 2018, la Galtiu, s-au desfăşurat şi ultimele partide contând pentru Campionatul Speranţelor „Dragoş Damian”. Competiţia juvenilă pe teren redus, la categoria Under 9 (copii din anul 2009), organizată de Asociaţia Judeţeană de Fotbal Alba în memoria lui Dragoş Damian, fostul căpitan al Interului Ciugud, ce a avut la start […]

În nicio localitate din judeţul Neamţ nu s-au înregistrat inundaţii sau pagube (17 iunie)
www.stiri-neamt.ro - Neamţ
Judeţului Neamţ i-a trecut glonţul pe la ureche în noaptea de sâmbătă spre duminică (16-17 iunie), cu toate că autorităţile se aşteptau la ceea ce este

MESAJUL lui ALEX VELEA pentru fanii săi, după ce a fost „DAT DISPĂRUT”
evz.ro - Bucureşti
După ce a dispărut complet din finala „Bravo, ai stil!”, cântăreţul Alex Velea a lansat un mesaj pentru fanii săi. Nimeni nu se aştepta la asta....

FOTO/VIDEO – Flamenco, tobe, culorile Columbiei, Bolero pe ritmuri tribale şi bunicuţe dansatoare ieri la FITS!
socialmedia.oradesibiu.ro - Sibiu
Flamenco este un dans care cucereşte şi impresionează publicul sibian an de an la FITS! Spectacolul văzut ieri, Sânge şi lumină, al “De Sangre y Raza” Flamenco Ballet, în coregrafia lui Juan Manuel…

COD GALBEN în Alba, duminică, până la ora 16.30 – Averse de ploaie, descărcări electrice şi grindină. Localităţile vizate
ziarulunirea.ro - Alba
O nouă avertizare cu cod galben a fost emisă de meteorologi, duminică, pentru judeţul Alba. Deocamdată este valabilă până la ora 16.30, dar există posibilitatea să fie prelungită. Sunt prognozate: Averse de ploaie care vor cumula 20-25 l/mp, descărcări electrice şi grindină de mici dimensiuni. Localităţile vizate sunt: Alba Iulia, Cugir, Zlatna, Câmpeni, Abrud, Ighiu, […]

VIDEO CLUJ - Un poliţist l-a doborât la pământ şi i-a aplicat trei pumni la ficat. Vi se pare normal?
www.stiridecluj.ro - Cluj
VIDEO CLUJ - Un poliţist a doborât la pământ un bărbat şi i-a aplicat trei pumni la ficat

DEZASTRU pe DN! CINCI persoane rănite, SMURD a intervenit de URGENȚĂ
evz.ro - Bucureşti
Cinci persoane au fost rănite duminică într-un accident rutier produs pe DN2, pe raza localităţii Cioranca, una dintre victime fiind transportată cu un elic...

Separatiştii din UMF Tîrgu Mureş au protestat singuri şi stingheri. ”Nu vrem NOI HOTARE, vrem DREPTURI EGALE”
evz.ro - Bucureşti
Un grup de 20 de persoane din UMF Tîrgu Mureş a făcut, sâmbătă, un miting de informare în Piaţa Victoriei, în faţa Guvernului. ...

Gusa: DNA Ploiesti este UM a Statului Paralel
ph-online.ro - Prahova
Mă uit pe Realitatea (de la căldură, cred): Guşă zice că există Stat Paralel, că DNA Ploieşti e UM a Statului Paralel, că nu e normal ca firmele şi oa...

Cod portocaliu de inundaţii pe râuri din 14 judeţe, până luni la ora 12.00
feedproxy.google.com - Braşov
Hidrologii au emis avertizări cod portocaliu de inundaţii pentru râuri din 14 judeţe, valabile până luni la ora 12.00. Fenomenele se pot produce cu probabilitate şi intensitate mai mare pe unele râuri mici din mai multe judeţe. Sub cod portocaliu de inundaţii se află bazine hidrografice din judeţele Harghita, Covasna, Braşov, Prahova, Buzău, Suceava, Neamţ,

Interventie salvatoare pe Lacul Razim. Patru persoane aflate intr-o ambarcatiune in pericol au ajuns in siguranta la mal
www.ziuaconstanta.ro - Constanţa
Patru persoane aflate intr-o ambarcatiune pe Lacul Razim, in zona localitatii Jurilovca au fost salvate cu ajutorul ambarcatiunii Primariei Jurilovca. Potrivit unui mesaj postat pe facebook de ...

FOTO/ ȘTIREA TA: Drumul ca duce la Peştera Scărişoara, UN DEZASTRU! Turiştii nu au nicio şansă să ajungă, dacă nu au maşini de teren
ziarulunirea.ro - Alba
”Drumul din comuna Scărişoara, ce leagă satele Purceleşti-Preluca-Negeşti-Sfoartea şi duce la peştera Ghetar, a fost făcut de mântuială de 10 ani şi acum este impracticabil. A fost umplut cu nisip şi bolovani, în prag de alegeri iar acum, după ploi, nu mai poţi urca nici cu maşini de teren, ce să mai vorbim de o […]

Interventie salvatoare pe Lacul Razim. Patru persoane aflate intr-o ambarcatiune au fost salvate
www.ziuaconstanta.ro - Constanţa
Patru persoane aflate intr-o ambarcatiune pe Lacul Razim, in zona localitatii Jurilovca au fost salvate cu ajutorul ambarcatiunii Primariei Jurilovca. Potrivit unui mesaj postat pe facebook de ...

GALERIE VIDEO – Dresură de cai şi întreceri cavalereşti, la Poalele Turnului Chindia, în cadrul Festivalului Dracula
www.gazetadambovitei.ro - Dâmboviţa

ANM a actualizat atenţionarea meteo pentru judeţul Neamţ. Cod GALBEN până luni, 18 iunie
www.stiri-neamt.ro - Neamţ
Administraţia Naţională de Meteorologie a emis astăzi (17 iunie) un nou cod galben de averse însemnate cantitativ valabil până luni, ora 5:00, pentru

A murit STRIVIT de SICRIUL mamei sale. RITUAL soldat cu un final TRAGIC
evz.ro - Bucureşti
Un bărbat indonezian a murit zdrobit de sicriul mamei sale, care a căzut de pe turnul funerar în timpul ceremoniei înmormântării pe insula Celebes, a anunţa...

Accident rutier pe DN2 in judetul Buzau. Cinci persoane au fost ranite, Elicopterul SMURD chemat in ajutorul victimelor
www.ziuaconstanta.ro - Constanţa
Cinci persoane au fost ranite in aceasta dupa amiaza intr-un grav accident rutier ce a avut loc pe DN2, pe raza localitatii Cioranca. Potrivit politistilor, pentru una dintre victime a fost solicitat ...

La „Decebal” s-a reaprins flacăra jurnalistică. După 10 ani fără „Interfeţe“!
expressdebanat.ro - Caraş-Severin
La finalul anului şcolar, Liceul Tehnologic Decebal din Caransebeş se poate mândri că a reeditat revista şcolii, „Interfeţe”. Este al doilea număr dintr-o revistă şcolară... la distanţă de zece ani faţă de primul număr, din 2008, mirajul cuvintelor tipărite şi răspândite pretutindeni şi-a găsit loc aici, in filele miracolului repetabil al generaţiilor de elevi, de profesori, mereu alţii, în structura aceluiaşi tipar uman.

Investiţie SDEE Transilvania Sud la Sighişoara
www.zi-de-zi.ro - Mureş
Conducerea Primăriei municipiul Sighişoara informează cetăţenii că în perioada 12 iunie - 1 noiembri

Septuagenar descarcerat la Valea Ursului
www.ziarulargesul.ro - Argeş
Patru oameni au ajuns la spital la sfârşitul săptămânii trecute, după ce vehiculele în care se aflau au fost implicate într-un accident rutier. Din fericire niciuna dintre victime nu avea răni grave. Evenimentul a avut loc pe DN 7 Piteşti - Râmnicu Vâlcea în jurul orei 15.30 a după-amiezii de...

Cui îi este LOIAL GABRIEL VLASE. Ce a spus TĂRICEANU despre posibilul ȘEF SIE
evz.ro - Bucureşti
Preşedintele ALDE, Călin Popescu-Tăriceanu, a declarat că nu are nicio rezervă în privinţa loialităţii lui Gabriel Vlase, propus de şeful statului....

ATENTAT la DISNEY World. Planul DIABOLIC pus la CALE de un tânăr de 23 de ani
evz.ro - Bucureşti
Un bărbat a fost arestat după ce autorităţile au constatat că acesta pusese la cale un plan diabolic. În vârstă de 23 de ani, bărbatul dorea să comită un at...

TENSIUNI între TĂRICEANU şi IOHANNIS. Șeful Senatului vrea REVOCAREA lui KOVESI
evz.ro - Bucureşti
Preşedintele ALDE, Călin Popescu-Tăriceanu, consideră că şeful statului, ca garant al Constituţiei, trebuie să semneze decretul de revocare a şefei DNA, Lau...

Constanta. Parinti sanctionati de politistii locali pentru ca isi foloseau copiii la cersit. Suspectii depistati in Tomis Nord (galerie foto)
www.ziuaconstanta.ro - Constanţa
Politistii locali din cadrul serviciilor operative de ordine publica ale Directiei Generale Politia Locala actioneaza zilnic atat din oficiu, cat si la solicitarea cetatenilor pentru depistarea celor ...

Gospodării afectate de inundaţii
www.ziarulargesul.ro - Argeş
Ploile abătute vineri seară asupra judeţului au creat din nou probleme serioase în Piteşti şi în alte câteva localităţi, aşa că, în intervalul 16 - 17 iunie, ISU Argeş a fost solicitat să intervină atât în municipiu, cât şi în unele comune. Astfel, 40 de pompieri cu 14 mijloace tehnice şi 14...

FITS 2018 ajunge la final – Spectacole de top în ultima zi a ediţiei aniversare
socialmedia.oradesibiu.ro - Sibiu
Gala Celebrităţilor din data de 16 iunie a fost prilejul revederii publicului FITS cu Mikhail Baryshnikov şi toţi ceilalţi artişti care au primit o stea pe Aleea Celebrităţilor din 2018: Isabelle…

Accident pe dealul Bitiilor. O femeie a fost rănită după ce maşina în care era s-a răsturnat în şanţul de pe marginea drumului
www.ebihoreanul.ro - Bihor
O femeie a fost rănită duminică în jurul orei 11 după de autoturismul Renault Laguna în care se afla s-a răsturnat în şanţul de pe marginea drumului. Pasagera a suferit o plagă la bărbie şi mai multe contuzii la cap şi coloană şi a fost scoasă din autovehicul avariat de o echipă de descarcerare a pompierilor militari din Beiuş. Poliţiştii rutieri efectuează cercetări la faţa locului pentru stabilirea cauzelor ieşirii maşinii în decor.

VIDEO – FOTO O maşină a luat foc în mers vizavi de Kaufland pe Doamna Stanca
www.oradesibiu.ro - Sibiu
Un autoturism marca Ford a luat foc în mers în timp ce se deplasa pe strada Doamna Stanca în direcţia de mers spre Dedeman. Șoferul a observat că iasă dum de la motor şi a oprit imediat autoturismul.

Prognoza meteo pentru duminică – Nu scăpăm nici cum de ploi
www.oradesibiu.ro - Sibiu
Meteorologii ne avertizează că vremea o să fie una capricioasă şi duminică după amiază, dar şi spre seară. În mai multe regiuni o să plouă. Nu scăpăm de ploi şi vijelii nici în orele următoare.

E nevoie de noi microbuze şcolare!
www.ziarulargesul.ro - Argeş
La propunerea Inspectoratului Şcolar Judeţean şi al primăriilor din Argeş sunt la Ministerul Dezvoltării Regionale în acest moment nu mai puţin de 70 de cereri pentru microbuze de transport şcolari. Maşinile solicitate sunt de diferite mărimi, adaptate nevoilor localităţilor. Din păcate...

Accident pe DN 17, la intersecţia Șintereag-Blăjeni. Doi bărbaţi şi un copil au ajuns la spital
www.timponline.ro - Bistriţa-Năsăud
Un accident rutier a avut loc pe DN 17, la intersecţia Șintereag-Blăjenii de Jos, în care au fost implicate două autoturisme. Una s-a răsturnat în afara părţii carosabile. La faţa locului au ajuns un echipaj de prim ajutor de la Beclean şi o ambulanţă SAJ-ISU.
În cele două maşini se aflau şapte p

60 de gospodarii inundate la Izvoarele
ziarulteleormanul.ro - Teleorman
Precipitatiile abundente cazute sambata si scurgerile de pe dealuri au inundat, in localitatea Iazvoarele, aproximativ 60 de gospodării, sase case de locuit, 30 de anexe şi trei autoturisme, informeaza ISU Teleorman. Pompierii militari împreună cu autorităţile locale au inceput, in aceasta dimineata, să evacueze apa din gospodării şi au luat măsura distrugerii unor podeţe ce împiedicau scurgerea rapidă a apei. Împreună cu autorităţile locale, care au adus un buldoexcavator, o motopompă, saci cu nisip şi mai mulţi oameni, pompierii militari intervin cu două motopompe de mare capacitate şi două

Prognoza meteo pentru duminică – Nu scăpăm nici cum de ploi
socialmedia.oradesibiu.ro - Sibiu
Meteorologii ne avertizează că vremea o să fie una capricioasă şi duminică după amiază, dar şi spre seară. În mai multe regiuni o să plouă. Nu scăpăm de ploi şi vijelii nici în orele următoare.

Milioane pentru piste de bicicletă
www.ziarulargesul.ro - Argeş
Primăria Piteşti a întocmit documentaţiile pentru atribuirea de servicii de proiectare şi scrierea cererii de finanţare în vederea atragerii de fonduri pentru realizarea de noi piste de biciclete şi amenajarea corespunzătoare a falezei Argeşului. 2 milioane euro ar urma să coste proiectul...

Se PREGĂTEȘTE o decizie BOMBĂ în cazul Kovesi - Antena 3. Cazul poate schimba LEGISLAȚIA din România
evz.ro - Bucureşti
La ÎCCJ poate avea loc o decizie cel puţin controversată după o sesizare formulată de Curtea de Apel Bucureşti la data de 21 martie 2018....

Infracţiune prin inacţiune: Un bihorean a fost condamnat la închisoare pentru că nu şi-a ajutat doi prieteni, care apoi au murit
www.ebihoreanul.ro - Bihor
Un bihorean a fost condamnat de Curtea de Apel Oradea, după ce, în urma unui accident, şi-a lăsat prinşi sub tractor doi prieteni împreună cu care se întorcea de la băut. Speriat, bărbatul a fugit acasă fără să anunţe autorităţile. Prima victimă a murit pe loc, iar cea de a doua trei zile mai târziu, la spital.

Elevii CN Mihai Eminescu Constanta au obtinut locul I la gimnastica aerobica la concursul "Dansam pentru sanatate"!
www.ziuaconstanta.ro - Constanţa
Desi vacanta a inceput, elevii CN Mihai Eminescu Constanta, participa la competitii! Astazi, in cadrul etapei regionale a Concursului de majorete si gimnastica aerobica Dansam pentru sanatate , ...

SECRETUL unei SILUETE perfecte dezvăluit de o VEDETĂ din România. Cum a reuşit să SLĂBEASCĂ 15 kilograme
evz.ro - Bucureşti
La aproape 50 de ani, una dintre cele mai frumoase artiste din România a reuşit să se menţină din punct de vedere fizic la un nivel ridicat....

IMAGINI INCENDIARE cu NEPOATA unui cunoscut MANELIST. A încins TOATĂ PLAJA cu formele ei - Galerie FOTO
evz.ro - Bucureşti
Roxana Dobriţoi, nepoata cunoscutului manelist Adi de la Vâlcea, a întors toate privirile de pe plajă cu formele ei atrăgătoare....

Produsul „Telemea de Sibiu” a primit protecţia naţională a sistemelor din domeniul calităţii
ziarulunirea.ro - Alba
Începând cu data de 7 iunie 2018, produsul „Telemea de Sibiu” a primit protecţia naţională a sistemelor din domeniul calităţii, conform legislaţiei europene şi naţionale. Dreptul de utilizare a logo-ului naţional cât şi dreptul de a comercializa produse din clasa 1.3 Brânzeturi cu denumirea „telemea de Sibiu” revine exclusiv producătorilor sau procesatorilor din arealul geografic, […]
![Neamţ: Se schimbă indicatoarele de direcţionare pe toate traseele turistice din Masivul Ceahlău [FOTO]](/showimg/300-200--zi/images/fullinfo.ro-images/news-186713.jpg)
Neamţ: Se schimbă indicatoarele de direcţionare pe toate traseele turistice din Masivul Ceahlău [FOTO]
www.stiri-neamt.ro - Neamţ
Începând de astăzi, 17 iunie, şi până în jurul datei de 5 iulie, Salvamont Neamţ va schimba indicatoarele de direcţionare pe toate traseele turistice din

O fată a fugit de acasă, dar lăsat în urmă un bilet şocant
evz.ro - Bucureşti
O fată a fugit de acasă, dar lăsat în urmă un bilet şocant...

Sfaturile IPJ Neamţ pentru a conduce în siguranţă pe timp de ploaie
www.stiri-neamt.ro - Neamţ
IPJ Neamţ reaminteşte şoferilor recomandările pentru circulaţie în siguranţă, în condiţii de ploaie. Sfaturile sunt menite să prevină accidentele. Pe

Legea gazelor, schimbată la propunerea primarilor din Argeş
www.ziarulargesul.ro - Argeş
Parlamentul a adoptat mai multe amendamente la Legea Gazelor care dau posibilitatea autorităţilor locale să investească în reţele de distribuţie a gazelor. Amendamentele au fost propuse şi susţinute de mai mulţi primari din Argeş. Iniţiativa legislativă a aparţinut senatorilor PSD de Argeş...

VIDEO – FOTO O maşină a luat foc în mers vizavi de Kaufland pe Doamna Stanca
socialmedia.oradesibiu.ro - Sibiu
Un autoturism marca Ford a luat foc în mers în timp ce se deplasa pe strada Doamna Stanca în direcţia de mers spre Dedeman. Șoferul a observat că iasă dum de la motor şi a oprit imediat autoturismul.

Un imobil al falimentarei CNM NAVROM, situat in incinta Port Constanta, scos la vanzare de lichidatorul judiciar
www.ziuaconstanta.ro - Constanţa
PricewaterhouseCoopers Business Recovery Services IPURL, in calitate de lichidator judiciar al Debitoarei C.N.M. NAVROM SA. CONSTANTA in faliment , in dosarul nr. 9 118 1998 nr. vechi 2643 com 1998 , aflat ...

Fenomen social tot mai răspândit: Oamenii împrumută emoţiile altora
www.zi-de-zi.ro - Mureş
Stările omului sunt precum crengile copacului, auxiliarele sale. Acestea cresc într-o formă sau alta

Piatra-Neamţ: Prins cu alcool şi ţigări de contrabandă. Poliţiştii i-au confiscat şi suma de 17.500 lei
www.stiri-neamt.ro - Neamţ
La data de 15 iunie 2018, poliţiştii Biroului Ordine Publică din cadrul Poliţiei Municipiului Piatra Neamţ au acţionat pe linia prevenirii şi constatării

Atena si Skopje au semnat acordul pentru redenumirea Fostei Republici Iugoslave a Macedoniei in Macedonia de Nord
ziarmm.ro - Maramureş
Ministrii de externe de la Atena si Skopje, Nikos Kotzias si Nikola Dimitrov, au semnat duminica, in localitatea de frontiera Prespes, in Grecia, acordul ce prevede schimbarea numelui actualei Foste R

Neamţ: Accident rutier cu două victime. Un şofer beat a intrat cu autoutilitara într-o căruţă
www.stiri-neamt.ro - Neamţ
În data de 16 iunie a.c., poliţiştii au intervenit la un accident rutier soldat cu victime, în localitatea Tupilaţi. Conform IPJ Neamţ, din primele

Adio furturi din autobuze
www.ziarulargesul.ro - Argeş
Una dintre problemele cu care se confruntă călătorii din Piteşti în prezent pe autobuzele Publitrans este riscul de a fi jefuiţi. Sunt anumite persoane care umblă uneori şi în grup pe mijloacele de transport şi fură din buzunare, uneori devenind şi violente, iar autorităţile nu au atâţia oameni...

„Spaima vitezomanilor” a ajuns în Neamţ! Noul radar-pistol a făcut zeci de „victime” în doar 2 ore
www.stiri-neamt.ro - Neamţ
Din luna iunie a.c., Serviciului Rutier Neamţ are în dotare unul dintre cele mai performante echipamente din dotarea poliţiei rutiere. - informează

BOMBĂ în showbiz! Bianca Drăguşanu s-a despărţit de Victor Slav. Detalii EXPLOZIVE. Motivul care a dus la RUPTURA DEFINITIVĂ
evz.ro - Bucureşti
Bianca Drăguşanu şi Victor Slav nu mai formează un cuplu! Cei doi s-au despărţit, lucru confirmat inclusiv de faptul că pe conturile personal de socializare...

Steagul Estoniei, pus invers la întâlnirea cu Dăncilă. VIDEO
evz.ro - Bucureşti
Steagul Estoniei, pus invers la întâlnirea cu Dăncilă. VIDEO...

FOTO – Ministrul Turismului, ghid pentru jurnaliştii străini la Sibiu. Pe unde i-a plimbat
www.oradesibiu.ro - Sibiu
Ministrul Turismului, Bogdan Trif, a fost ghid pentru o zi pentru jurnaliştii străini care au venit în România în cadrul unei vizite de documentare. Paisprezece reprezentanţi mass-media din Cehia…

Grecia fierbe! Locuitorii protestează în stradă împotriva redenumirii fostului stat iugoslav în "Republica Macedonia de Nord"
www.ebihoreanul.ro - Bihor
Val de proteste în Grecia, după ce ministrul grec de Externe Nikos Kotzias şi omologul său macedonean Nicola Dimitrov au semnat duminică, în nordul Greciei, lângă frontiera cu Macedonia şi Albania un acord istoric prin care numele fostei republici iugoslave devine 'Republica Macedonia de Nord'. Protestatarii susţin că premierul grec Alexis Tsipras, care a supravieţuit sâmbătă la limită unui vot de neîncredere în Parlament, le-a făcut prea multe concesii macedonenilor în condiţiile în care una din regiunile nordice ale Greciei poartă aceeaşi denumire.

Corespondenţă din Paris – Minunile parfumului
www.ziarulargesul.ro - Argeş
Din fragedă tinereţe am avut o sensibilitate olfactivă deosebită. O fată oricât de frumoasă mă cucerea în primul rând cu mirosul. O porţie de tocană la fel. Şi am rămas aşa. Din acest motiv am făcut o vizită în capitala mondială a parfumului de lux, oraşul Grasse, din sudul Franţei. Muzeul...

FOTO, LIVE-TEXT, la Galtiu, Transalpina Șugag – Sportul Petreşti, finala Cupei României, faza judeţeană | Trofeul, în premieră pentru finaliste
ziarulunirea.ro - Alba
Astăzi, de la ora 18.00, pe Stadionul din Galtiu, două formaţii de pe Valea Sebeşului, Transalpina Șugag şi Sportul Petreşti, se înfruntă pentru câştigarea, în premieră a Cupei României, faza judeţeană. Trofeul reprezintă o miză însemnată pentru cele două grupări clasate pe podiumul Ligii a IV-a, după ce au visat etape bune la câştigarea campionatului. […]

„Attenborough şi Dinozaurul gigantic“ închide British Documentary la Târgu-Mureş
www.zi-de-zi.ro - Mureş
Ultima proiecţie din cadrul celei de-a şaptea ediţii British Documentary la Târgu-Mureş, desfăşurată

Viorica Dăncilă, HUIDUITĂ la Constanţa: „Nu are ce căuta în fruntea Guvernului. Ar fi trebuit să îi aducem un abecedar”.
evz.ro - Bucureşti
Premierul Viorica Dăncilă, prezentă la inaugurarea Consulatului Onorific al Estoniei la Constanţa, a fost huiduită de
câţiva protestatari cu pancarte ...

AMR le răspunde „plecaţilor pe uşa din dos” din Filiala Cluj a asociaţiei
www.zi-de-zi.ro - Mureş
Asociaţia Magistraţilor din România (AMR), a cărei preşedinte interimar este judecătoarea mureşeană

FOTO – Ministrul Turismului, ghid pentru jurnaliştii străini la Sibiu. Pe unde i-a plimbat
socialmedia.oradesibiu.ro - Sibiu
Ministrul Turismului, Bogdan Trif, a fost ghid pentru o zi pentru jurnaliştii străini care au venit în România în cadrul unei vizite de documentare. Paisprezece reprezentanţi mass-media din Cehia…

Sporting Piteşti – CS Zlatna 5-1 (2-0), în meci decisiv la juniori A1, pentru calificarea în semifinale
ziarulunirea.ro - Alba
Sporting Piteşti (campioana en titre) şi CS Zlatna s-au duelat într-un meci decisiv pentru calificarea între primele 4 formaţii din ţară la juniori A1, amfitrionii impunându-se cu scorul de 5-1 (2-0). Aurarii au avut doi oamenii eliminaţi pe Bustan şi Negrea (ambii în actul secund), Bradu marcând în minutul 84 golul de onoare, la scorul […]

Scene SCANDALOASE în SPITAL. O ASISTENTĂ, lovită CRUNT de un BĂRBAT. A fost internată de URGENȚĂ
evz.ro - Bucureşti
Scene violente la un Spitalul Clinic Judeţean Braşov. O asistentă a fost lovită puternic de un bărbat beat şi acum este internată la neurochirurgie....

O ursoaică rămasă captivă, eliberată cu ajutorul jandarmilor
ziarharghita.ro - Harghita
Sâmbătă, 17 iunie, în jurul orei 04:00, jandarmii harghiteni au eliberat o ursoaică ce a rămas blocată în interiorul unui container, în apropierea gării din Băile Tuşnad. Astfel, în jurul orei 03:00, un bărbat a sunat prin intermediul SNUAU 112 pentru a anunţa că în apropierea gării din staţiunea Băile Tuşnad,

Avertizare nowcasting. Averse, descarcari electirce, intensificari ale vantului in Dobrogea
www.ziuaconstanta.ro - Constanţa
Administratia Nationala de Meteorologie a emis o avertizare nowcasting valabil, astazi , in intervalul 13 00- 14 00. Sunt vizate urmatoarele localitati Constanta, Navodari, Ovidiu, Murfatlar, Mihail ...

Un parlamentar clujean ar urma să treacă la ALDE
www.stiridecluj.ro - Cluj
Un parlamentar clujean ar urma să treacă la ALDE

VIDEO CLUJ - Un poliţist l-a doborât la pământ şi i-a aplicat trei pumni la ficat. Vi se pare normal?
www.stiridecluj.ro - Cluj
VIDEO CLUJ - Un poliţist a doborât la pământ un bărbat şi i-a aplicat trei pumni la ficat

Imagini de la eveniment: Campionatul National de Kung-Fu se desfasoara astazi la Constanta. Intrarea e libera (galerie foto)
www.ziuaconstanta.ro - Constanţa
Editia 2018 a Campionatului National de Kung-Fu, la probele de Sanda , Total-Contact Fighting si Erjie-Gun Fight , copii, cadeti, juniori si seniori, se desfasoara astazi la Constanta, la ...

Final de stagiune la Teatrul Gong – Spectacole jucate pentru ultima data anul acesta
www.oradesibiu.ro - Sibiu
Teatrul pentru Copii şi Tineret „Gong” Sibiu prezintă pentru ultima dată în acest an spectacolele „Vrăjitorul din Oz” în regia Simonei Vintilă şi „Hänsel şi Gretel” în regia Oanei Leahu. Cei mici se…

VIDEO CLUJ - Un poliţist l-a doborât la pământ şi i-a aplicat trei pumni la ficat. Vi se pare normal?
www.stiridecluj.ro - Cluj
VIDEO CLUJ - Un poliţist a doborât la pământ un bărbat şi i-a aplicat trei pumni la ficat

Două transporturi de ţigări de contrabandă, depistate în doar o oră
feeds.monitorulsv.ro - Suceava
Ultima ora: Doua transporturi cu tigari de contrabanda, dintre care unul trebuia sa ajunga in Italia, au fost depistate sambata dimineata, in decurs de numai o ora. Politistii Postului de Politie Vama au oprit in jurul orei 05.00, pe DN 17 A, pe raza comunei Vatra Moldovitei, autoturismul marca Audi A4, condus de un tanar de 28 de ani, din Bilca.

FAMILIA REGALĂ, implicată într-un ACCIDENT. Soţia PRINȚULUI, rănită GRAV
evz.ro - Bucureşti
Prinţul Cambodgiei a fost implicat într-un accident rutier în provincial Preah Sihanouk, anunţă agenţiile de ştiri din întreaga lume....

Cronici Britanice: De la 1 Mai laburist la Sărbători Marxiste Fericite
www.zi-de-zi.ro - Mureş
Nu ştiu cum sunt alţii, dar eu unul, binecuvântat cu experienţa deopotrivă a binefacerilor comunismu

VIDEO CLUJ - Un poliţist l-a doborât la pământ şi i-a aplicat trei pumni la ficat. Vi se pare normal?
www.stiridecluj.ro - Cluj
VIDEO CLUJ - Un poliţist a doborât la pământ un bărbat şi i-a aplicat trei pumni la ficat

Proiect de lege depus de PMP: Şoferii prinşi la volan cu dispozitive audio-video sau depistaţi ulterior prin postări pe reţele sociale şi mass-media să rămână fără permis”
ziarulunirea.ro - Alba
Un deputat PMP a depus un proiect de lege care prevede ca şoferii prinşi că folosesc telefoanele mobile în timp ce conduc sau sunt identificaţi ulterior, prin postări pe reţelele de socializare sau în mass-media, să fie sancţionaţi cu suspendarea permisului de conducere pentru 90 de zile. Movilă mai vrea ca amenzile şi punctele de […]

A incetat din viata istoricul si criticul literar Dumitru Micu
www.ziuaconstanta.ro - Constanţa
Muzeul National al Literaturii Romane se alatura tuturor celor care deplang disparitia celui care a fost Dumitru Micu. Acesta a plecat dintre noi duminica, 17 iunie 2018, la varsta de 89 de ani. Dumitru ...

VIDEO CLUJ - Un poliţist l-a doborât la pământ şi i-a aplicat trei pumni la ficat. Vi se pare normal?
www.stiridecluj.ro - Cluj
VIDEO CLUJ - Un poliţist a doborât la pământ un bărbat şi i-a aplicat trei pumni la ficat

Final de stagiune la Teatrul Gong – Spectacole jucate pentru ultima data anul acesta
socialmedia.oradesibiu.ro - Sibiu
Teatrul pentru Copii şi Tineret „Gong” Sibiu prezintă pentru ultima dată în acest an spectacolele „Vrăjitorul din Oz” în regia Simonei Vintilă şi „Hänsel şi Gretel” în regia Oanei Leahu. Cei mici se…

FOTO/ Accident rutier în Alba Iulia: Coliziune între două autoturisme, în apropiere de Alba Mall. 3 persoane rănite uşor în urma impactului
ziarulunirea.ro - Alba
Un accident rutier soldat cu rănirea uşoară a trei persoane s-a produs, duminică în jurul prânzului, pe str. Tudor Vladimirescu din Alba Iulia. ”Trafic îngreunat pe b-dul Tudor Vladimirescu din Alba Iulia, in apropiere de mall, datorită unui accident in care sunt implicate doua autoturisme. 3 persoane posibil rănite uşor. Cauza probabilă neacordarea de prioritate”, […]

Eveniment ISTORIC! STAT NOU în Europa. ACORDUL a fost SEMNAT duminică
evz.ro - Bucureşti
Gest istoric realizat duminică. Miniştrii de externe de la Atena şi Skopje au semnat acordul pentru redenumirea Fostei Republici Iugoslave a Macedoniei în M...

Publicatia Charlie Hebdo“, actionata in instanta pentru caricatura prin care o ironizeaza pe Simona Halep
www.ziuaconstanta.ro - Constanţa
FADERE Federatia asociatiilor de romani din Europa a anuntat ca, sprijinita de Ccasa de Avocatura Paredes y Asociados va deschide, in cursul zilei de maine, un proces impotriva publicatiei Charlie ...

Interventie ISU. Miros de gaze pe strada Cpt. Dobrila Eugeniu din municipiul Constanta
www.ziuaconstanta.ro - Constanţa
Miros puternic de gaze pe strada Cpt. Dobrila Eugeniu nr.1 A din municipiul Constanta. La fata locului au ajuns reprezentantii ISU Dobrogea care asigura masuri de prevenire si stingere a incediilor. ...

Egiptul a majorat pretul benzinei la pompa cu 50%
ziarmm.ro - Maramureş
Ministerul Petrolului din Egipt a majorat sambata pretul benzinei cu pana la 50%, in conformitate cu reformele convenite cu Fondul Monetar International, printre care se numara si eliminarea subventii

În cazul în care vremea va fi nefavorabilă, spectacolele Festivalului Dracula se mută la Teatrul Tony Blandra
www.gazetadambovitei.ro - Dâmboviţa
COMUNICAT DE PRESĂ Probabilitate mutare locaţie evenimente pentru cea de-a III-a zi a Festivalului Medieval Dracula 2018 În cazul unor

Va mai trece o vreme pana vom circula pe autostrada Sebes-Turda. Vezi cum arata santierul! VIDEO
www.stiridecluj.ro - Cluj
Constructorul lotului I al autostrazii Sebes-Turda a angajat deja 400 de muncitori si inca...

În cazul în care vremea va fi nefavorabilă, spectacolele Festivalului Dracula se mută la Tetarul Tony Blandra
www.gazetadambovitei.ro - Dâmboviţa
COMUNICAT DE PRESĂ Probabilitate mutare locaţie evenimente pentru cea de-a III-a zi a Festivalului Medieval Dracula 2018 În cazul unor

ELITA românească, CUTREMURATĂ de o TRAGEDIE. Anunţul făcut de dimineaţă
evz.ro - Bucureşti
Pierdere uriaşă pentru cultura românească. Istoricul şi criticul literar Dumitru Micu a încetat din viaţă la vârsta de 89 de ani. Anunţul a fost făcut de Mu...

Trump are numai cuvinte de laudă despre Ungaria. În conversaţia telefonică l-a îndemnat pe Orban să NU RENUNŢE la apărarea frontierelor
evz.ro - Bucureşti
Trump l-a sunat pe premierul Ungariei să-l felicite în primul rând pentru modul cum luptă pentru apărarea frontierelor şi despre noul ambasador al SUA care ...

Zi de SĂRBĂTOARE la una dintre cele mai mari TELEVIZIUNI din ţară. O VEDETĂ de la ANTENA 1 a spus „DA”
evz.ro - Bucureşti
Este zi de sărbătoare la una dintre cele mai mari televiziuni din ţară. O mare vedetă de la Antena 1 a făcut pasul cel mare....

Va mai trece o vreme pana vom circula pe autostrada Sebes-Turda. Vezi cum arata santierul! VIDEO
www.stiridecluj.ro - Cluj
Constructorul lotului I al autostrazii Sebes-Turda a angajat deja 400 de muncitori si inca...

Curaj pe tocuri: Marele câştigător al show-ului "Românii au talent", orădeanul Emil Rengle, este un promotor al toleranţei faţă de comunitatea gay (FOTO)
www.ebihoreanul.ro - Bihor
Marele câştigător al show-ului 'Românii au talent', orădeanul Emil Rengle, este un promotor al toleranţei faţă de comunitatea gay din România. Deşi unii i-au contestat talentele de dansator şi coregraf, iar alţii l-au jignit după ce a dezvăluit că este bisexual, artistul a decis să ignore răuvoitorii, spunând că triumful său în emisiunea PRO TV demonstrează schimbarea mentalităţilor românilor.

Asistentă medicală agresată de un individ beat la Judeţean
feedproxy.google.com - Braşov
Azi-noapte, în jurul orei 1.45, poliţiştii au fost sesizati că un barbat de 29 ani, din municipiul Bucuresti, ce fusese transportat de un echipaj SMURD la Unitatea de Primiri Urgente, aflat sub influenta bauturilor alcoolice, în încercarea de a părăsi sectia, a împins o asistenta medicala de 43 ani, din municipiul Braşov. Aceasta s-a lovit

Accident rutier în Alba Iulia: Coliziune între două autoturisme, în apropiere de Alba Mall. 3 persoane rănite uşor în urma impactului
ziarulunirea.ro - Alba
Un accident rutier soldat cu rănirea uşoară a trei persoane s-a produs, duminică în jurul prânzului, pe str. Tudor Vladimirescu din Alba Iulia. ”Trafic îngreunat pe b-dul Tudor Vladimirescu din Alba Iulia, in apropiere de mall, datorită unui accident in care sunt implicate doua autoturisme. 3 persoane posibil rănite uşor. Cauza probabilă neacordarea de prioritate”, […]

O casa din Dej s-a prabusit, iar o alta sta sa cada din cauza indiferentei autoritatilor VIDEO
www.stiridecluj.ro - Cluj
dej, casa prabusita, video

O casa din Dej s-a prabusit, iar o alta sta sa cada din cauza indiferentei autoritatilor VIDEO
www.stiridecluj.ro - Cluj
dej, casa prabusita, video

Hit -ul Mondialului din 1990 a răsunat pe Cluj Arena, cântat de Ad Libitum - VIDEO
www.stiridecluj.ro - Cluj
Hit -ul Mondialului din 1990 a răsunat pe Cluj Arena, cântat de Ad Libitum - VIDEO

Reprezentantii Miscarii #Rezist din Constanta au ajuns la Universitatea Ovidius. Ce mesaj au pentru premierul Dancila!
www.ziuaconstanta.ro - Constanţa
...

BOMBA. Daniel Zamfir trece de la PNL la ALDE: E cea mai neagră şi ruşinoasă eră a partidului
ph-online.ro - Prahova
Mişcare-şoc pe scena politică. Senatorul Daniel Zamfir a trecut la ALDE, după ce sâmbătă seară şi-a anunţat demisia de la PNL. Anunţul a fost făcut în...

Investiţii importante în Piaţa Agroalimentară 1848 din Târgu-Mureş
www.zi-de-zi.ro - Mureş
Cu sprijinul Primăriei şi Consiliului Local Târgu-Mureş, SC Administrator Imobile şi Pieţe SRL, soci

O casa din Dej s-a prabusit, iar o alta sta sa cada din cauza indiferentei autoritatilor VIDEO
www.stiridecluj.ro - Cluj
dej, casa prabusita, video

Un tânăr de 23 de ani a fost înjunghiat mortal într-o discotecă, sambata noapte
ph-online.ro - Prahova
Crimă cumplită la o discotecă din judeţul Iaşi. Un tânăr de 23 de ani a fost înjunghiat mortal sâmbătă noapte, în urma unui conflict spontan. Incident...

VIDEO CLUJ - Un poliţist l-a doborât la pământ şi i-a aplicat trei pumni la ficat. Vi se pare normal?
www.stiridecluj.ro - Cluj
VIDEO CLUJ - Un poliţist a doborât la pământ un bărbat şi i-a aplicat trei pumni la ficat

Cod PORTOCALIU de inundatii in Prahova
ph-online.ro - Prahova
Institutul National de Hidrologie si Gospodarire a Apelor a emis cod portocaliu şi cod galben de inundaţii pentru mai bine de jumătate de ţară. Codul...

Prognoza meteo în toată ţara: cod PORTOCALIU şi cod GALBEN de ploi torenţiale
ph-online.ro - Prahova
Duminică vremea va fi instabilă, cu averse destul de consistente. Instabilitatea persistă, vor fi tunete, fulgere, vânt cu răbufniri frecvente şi va p...

Senatorul Daniel Zamfir s-a inscris in ALDE
www.ziuaconstanta.ro - Constanţa
Senatorul Daniel Zamfir, exclus din Partidul National Liberal la sfarsitul lunii martie, a anuntat duminica, intr-o conferinta de presa sustinuta alaturi de presedintele ALDE, Calin ...

ULTIMA ORĂ - Atena şi Skopje au semnat: s-a schimbat numele Macedoniei
ph-online.ro - Prahova
După douăzeci şi şapte de ani de certuri politice şi semantice, Atena şi Skopie au ajuns, în fine, la un acord cu privire la numele fostei Republici I...

VIDEO CLUJ - Un poliţist l-a doborât la pământ şi i-a aplicat trei pumni la ficat. Vi se pare normal?
www.stiridecluj.ro - Cluj
VIDEO CLUJ - Un poliţist a doborât la pământ un bărbat şi i-a aplicat trei pumni la ficat

Atentie, clujeni! Accesul spre Taietura Turcului e inchis astazi pentru efectuarea unor lucrari
www.stiridecluj.ro - Cluj
Sucursala Regională CF Cluj a anuntat ca inchiderea totala a circulatiei rutiere pentru e...

Atentie, clujeni! Accesul spre Taietura Turcului e inchis astazi pentru efectuarea unor lucrari
www.stiridecluj.ro - Cluj
Sucursala Regională CF Cluj a anuntat ca inchiderea totala a circulatiei rutiere pentru e...

Atentie! Accesul spre Taietura Turcului e inchis astazi pentru efectuarea unor lucrari
www.stiridecluj.ro - Cluj
Sucursala Regională CF Cluj a anuntat ca inchiderea totala a circulatiei rutiere pentru e...

Gospodărie din comuna Șugag afectată de furtună – Torenţii au distrus gardul, au inundat curtea şi au avariat o anexă
ziarulunirea.ro - Alba
Potrivit ISU Alba, în urma precipitaţiilor abundente din data de 16.06.2018 la nivelul judeţului a fost afectată o singură gospodărie, din comuna Șugag, unde torenţii au distrus gardul pe o lungime de 50 de metri, au inundat curtea şi au avariat o anexă. Serviciul Voluntar pentru Situaţii de Urgenţă Șugag a intervenit cu mai mulţi […]

Suveranul pontif condamnă avorturile şi le compară cu practica nazistă de purificare a rasei
evz.ro - Bucureşti
Papa Francisc a denunţat sâmbăta avortul, considerând că este vorba de ”eugenie”-teorie care preconizeaza ameliorarea populaţiilor umane prin măsuri genetic...

Preotul Chris Terhes: Lumea începe să-şi pună întrebări despre ce se întâmplă cu adevărat în România. Miting PSD
evz.ro - Bucureşti
Chris Terhes, preşedintele Coaliţiei Românilor pentru Combaterea Corupţiei, a declarat că Mitingul anti-abuzuri organizat de PSD a fost privit cu atenţie....

Inspectorii ANAF au descins intr-un targ auto din Capitala
www.ziuaconstanta.ro - Constanţa
Targul AutoVit din Bucuresti a fost luat cu asalt de inspectorii ANAF, in aceasta dimineata.. Toate portile au fost inchise si se fac verificari in randul comerciantilor. ...

Cod galben de inundatii la Cluj pana luni la ora 24.00. Alte 14 judete din tara sunt sub cod portocaliu de inundatii
www.stiridecluj.ro - Cluj
Meteorologii au emis o avertizare de cod galben de inundatii pentru bazinele hidrografice ...

Un bicorn atribuit imparatului Napoleon, gasit la Waterloo si estimat la 2 milioane de euro, scos la licitatie
ziarmm.ro - Maramureş
"Napoleonomania" ar putea sa se manifeste inca o data saptamana viitoare, cand un bicorn (palarie barbateasca cu doua colturi, n.r.) atribuit imparatului Napoleon, gasit pe campul de batalie de la Wat

ALERTĂ pe scena POLITICĂ din ROMÂNIA. Un lider PNL a trecut la ALDE, sub aripa lui TĂRICEANU
evz.ro - Bucureşti
Călin Popescu Tăriceanu l-a prezentat duminică, în cadrul unei conferinţe de presă, pe cel mai nou membru al partidului ALDE, Daniel Zamfir, fost senator PN...

ULTIMĂ ORĂ: Scandal cu săbii şi bâte în bazarul auto din Focşani
www.jurnaldevrancea.ro - Vrancea
Un scandal de proporţii a izbucnit duminică dimineaţă în bazarul auto din Focşani. Patru tineri au scos săbiile şi bâtele la înaintare şi au încercat

ISU Neamţ: Două misiuni de evacuare apă din locuinţă, după inundaţii
www.stiri-neamt.ro - Neamţ
Sâmbătă, 16.06.2018, la ora 06:50, Dispeceratul Integrat ISU - Ambulanţă al judeţului Neamţ a fost anunţat prin numărul unic pentru apeluri de urgenţă

Inaugurarea consulatului onorific al Estoniei la Constanta!
www.ziuaconstanta.ro - Constanţa
In acest moment are loc inaugurarea consulatului onorific al Estoniei la Constanta. La eveniment participa primul ministru al Estoniei, Juri Ratas, primul ministru al Romaniei, Viorica Dancila, primarul ...

Încă o dovadă de prostie din partea Poliţiei Locale
feedproxy.google.com - Braşov
Cum e turcul şi pistolul. Aşa spune o veche zicere românească. La noi, cum e şeful Poliţiei Locale (individul ăla care se plimbă cu maşina instituiei prin ţară după bunul plac, pe bani publici), se pare că aşa sunt şi unii angajaţi. Iată ce a păţit un tânăr braşovean, pe care soarta l-a ţinutuit într-un
![Sute de credincioşi, prezenţi la Mănăstirea Petru-Vodă, cu prilejul pomenirii părintelui Justin Pârvu [VIDEO]](/showimg/300-200--zi/images/fullinfo.ro-images/news-186611.jpg)
Sute de credincioşi, prezenţi la Mănăstirea Petru-Vodă, cu prilejul pomenirii părintelui Justin Pârvu [VIDEO]
www.stiri-neamt.ro - Neamţ
Sute de credincioşi au fost prezenţi sâmbătă, 16 iunie, la Mănăstirea Petru-Vodă din judeţul Neamţ, cu prilejul pomenirii părintelui Justin Pârvu. Sfânta

Cozmin Guşă aruncă o informaţie explozivă: Ambasada SUA din R. Moldova ar putea fi mutată la Bucureşti
evz.ro - Bucureşti
Consultantul politic Cozmin Guşă a dezvăluit în cadrul emisiunii REALITATEA ROMÂNEASCĂ că „nişte think tank-uri” care lucrează „aproape de Casa Albă” opere...

Cui a atribuit Primaria Constanta contractul de achizitie de telefoane mobile
www.ziuaconstanta.ro - Constanţa
Primaria achizitioneaza un lot de telefoane mobile de ultima generatie necesare desfasurarii activitatii angajatilor din Primaria municipiului Constanta. Contractul de furnizare de telefoane ...

Rumegători de Oradea: Zona centrală a oraşului este pavată cu gumele de mestecat ale needucaţilor
www.ebihoreanul.ro - Bihor
Milioane de euro s-au cheltuit pentru reabilitarea Pieţei Unirii, a Pasajului Vulturul Negru şi a străzii Vasile Alecsandri, dar asta nu pare să-i fi impresionat pe fiţoşii care populează terasele din zonă şi care, la plecare, îşi lasă ADN-ul pe caldarâm. Aproape că nu există metru pătrat de piatră, mai ales în jurul teraselor, care să nu fie 'îmbulinat' cu zeci de gume de mestecat.

FOTO/ ȘTIREA TA: La Sebeş, apa de la primărie face concurenţă apei de ploaie iar gazonul este udat cu furtunul, chiar şi pe ploaie torenţială
ziarulunirea.ro - Alba
Situaţie hilară la la Sebeş unde gazonul este udat chiar şi atunci când plouă cu găleata. Ieri seară, angajaţii primăriei au fost surprinşi ”în acţiune”, făcând concurenţă ploii torenţiale care s-a abătut peste oraş. Cititorul care ne-a trimis poza consideră că, în aceste condiţii, nu era cazul să se facă risipă şi să se încarce […]

Tânăra care a omorât un om pe trecerea de pietoni consumase cocaină şi THC
www.gazetadambovitei.ro - Dâmboviţa
Tesatul de narcodependenţă realizat de medicii târgovişteni în cazul tinerei care a accidentat mortal un bărbat, pe trecerea de pietoni,

Dubiţele dintre blocuri, un real pericol
www.ziarulargesul.ro - Argeş
La Complexul I al cartierului Trivale, în apropiere de blocul P13 există o stradă ce pune multiple probleme locatarilor din cauza curbei formate printre blocuri. Vizibilitatea şi aşa destul de redusă este şi mai îngreunată de maşinile de marfă parcate la voia întâmplării, chiar în stradă. Dubele...

Pană de curent la Spitalul Judeţean de Urgenţă din Piatra-Neamţ, în această dimineaţă
www.stiri-neamt.ro - Neamţ
Spitalul Judeţean de Urgenţă din Piatra-Neamţ a rămas fără curent, duminică (17 iunie) dimineaţă, timp de aproximativ două ore. Alimentarea cu energie

Messi, DEVASTAT după penalty-ul RATAT în meciul cu Islanda
evz.ro - Bucureşti
Argentina s-a încurcat, ieri, cu Islanda, scor 1-1, la debutul în Campionatul Mondial din Rusia. „Pumele” se puteau desprinde, dar Lionel Messi a ratat surp...

Spitalului Judeţean de Urgenţă din Piatra-Neamţ a rămas fără curent în această dimineaţă
www.stiri-neamt.ro - Neamţ
Spitalului Judeţean de Urgenţă din Piatra-Neamţ a rămas fără curent, duminică (17 iunie) dimineaţă, timp de aproximativ două ore. Alimentarea cu energie

Proiect pentru extinderea Hotelului Făget
www.zi-de-zi.ro - Mureş
Agenţia pentru Protecţia Mediului (APM) Mureş anunţă publicul interesat asupra luării deciziei etape

ACUM – Accident în lanţ pe Bd. Republicii
www.ziarulargesul.ro - Argeş
Unul mai deştept ca altul, cam aşa ar putea fi sintetizat evenimentul care a avut loc în urmă cu nici o oră pe Bd. Republicii din Piteşti. Deşi artera de circulaţie era aproape goală, specific dimineţilor de weekend, doi şoferi şi o şoferiţă s-au încălecat într-un carambol de zile mari, după ce...

Prognoza meteo. Instabilitatea atmosferica pe litoral
www.ziuaconstanta.ro - Constanţa
Pe litoral sunt asteptate ceva schimbari in zilele care urmeaza, informeaza meteorologii. Duminica, atmosfera devine tot mai instabila, apare si soarele printre nori si probabil ca o sa ploua in ...

Operaţiune de salvare atipică în Harghita. Ursoaică eliberată de jandarmi dintr-un tomberon
evz.ro - Bucureşti
Jandarmii din Harghita au avut noaptea trecută o misiune deosebită. Au eliberat o ursoaică blocată într-un tomberon.
...

Gustul dulce… mulţi clienţi aduce! Calitate şi prospeţime la Cofetăria-Gelaterie Delice din Caransebeş
expressdebanat.ro - Caraş-Severin
O nouă afacere de succes s-a deschis de curând la Caransebeş. De acum gustul verii are mai multă prospeţime, savoare şi calitate odată cu apariţia pe piaţă a produselor oferite de Cofetăria-Gelaterie Delice.

Judecatorii clujeni si-au dat demisia din Asociatia Magistratilor din Romania, protestand fata de centru
www.stiridecluj.ro - Cluj
Judecatorul Cristi Danilet a anuntat dizolvarea filialei Cluj a Asociatiei Magistratilor d...

Judecatorii clujeni si-au dat demisia din Asociatia Magistratilor din Romania. protestand fata de centru
www.stiridecluj.ro - Cluj
Judecatorul Cristi Danilet a anuntat dizolvarea filialei Cluj a Asociatiei Magistratilor d...

Relicvă creştină descoperită în tomberoanele Londrei
evz.ro - Bucureşti
O descoperire cu totul şocantă a fost făcută de lucrătorii unei companii de deşeuri din Londra. Aceştia au găsit un relicvariu care conţine un os al Sfântului Clement....

Afganistan: 26 de persoane au fost ucise în urma unui atac cu maşină capcană
evz.ro - Bucureşti
Afganistan:26 de persoane au fost ucise în urma unui atac cu maşină capcană, după ce un atentator sinucigaş a detonat bomba pe care o avea la bord....

Ilie Năstase SE RĂZBOIEȘTE cu Poliţia Rutieră. Ce le-a cerut judecătorilor
evz.ro - Bucureşti
După ce a fost încătuşat şi deposedat de permis de Poliţia Rutieră, în urmă cu o lună, Ilie Năstase îşi caută acum dreptatea....

Echipa de juniori Under-15 de la FC Viitorul a ratat calificarea in finala Campionatului National
www.ziuaconstanta.ro - Constanţa
La Craiova au continuat intrecerile turneului semifinal de juniori U-15 jucatori nascuti dupa 1 ianuarie 2003 . Dupa 3-0 in prima zi cu FC Danut Coman, FC Viitorul U-15 antrenori, Ionut Mihu si ...

Cătălin Cristache a fost ales vicepreşedinte al PMP la congresul de sâmbătă
stiridegalati.ro - Galaţi
Noul preşedinte este Eugen Tomac.

Atenţie şoferi! Turul ciclist „Hospice Bike Tour” trece astăzi, 17 iunie, prin Neamţ
www.stiri-neamt.ro - Neamţ
Centrul INFOTRAFIC din Inspectoratul General al Poliţiei Române informează că, în perioada 15-19.06.2018, se desfăşoară "Hospice Bike Tour", tur cu

Finantele solicita studii de impact pentru o eventuala limitare a gradului de indatorare a populatiei
ziarmm.ro - Maramureş
Ministerul Finantelor Publice considera ca masurile macroprudentiale, respectiv limitele impuse gradului de indatorare a populatiei, trebuie implementate doar in urma unor studii de impact complet fun

CS Medgidia, la un pas de promovarea in Liga a 3-a. Egal cu Sportul Ciorasti
www.ziuaconstanta.ro - Constanţa
Castigatoarea Ligii a 4-a de fotbal a judetului Constanta, CS Medgidia, a luat o optiune serioasa pentru accederea in Liga a 3-a, dupa prima mansa a barajului de promovare. Jucatorii antrenati de ...

Tentativă de crimă la 1.200 de metri altitudine
evz.ro - Bucureşti
Un sergent al armatei britanice a fost condamnat la închisoare pe viaţă, după ce a sabotat paraşutele soţiei sale. ...

ABUZ de IMUNITATE DIPLOMATICĂ. Cum încearcă un MARE JUCĂTOR DE TENIS să scape de PROCEDURILE JURIDICE
evz.ro - Bucureşti
Fostul jucător de tenis german Boris Becker se prevalează de imunitate diplomatică într-o încercare de a scăpa de procedurile juridice ale falimentului pers...

Liderul UDMR comentează scenariul suspendării Preşedintelui: „Fără respectarea deciziilor instanţelor vom ajunge în anarhie”
evz.ro - Bucureşti
Preşedintele UDMR, Kelemen Hunor, este de părere că, în acest moment, nu există motive de suspendare a preşedintelui Klaus Iohannis şi că un posibil demers ...

Lucrari de reparatii si renovare la Pavilionul Expozional Constanta
www.ziuaconstanta.ro - Constanţa
Consiliul Judetean Constanta achizitioneaza executie lucrari de reparatii si reabilitare la platforme, cai de acces si instalatii electrice exterioare din incinta Pavilionului ...

Despre grijile vietii
www.ziuaconstanta.ro - Constanţa
,,Spune-Mi, daca stii sa spui. Care drum duce la palatul luminii sicare este locul intunericului? Poti tu cu adevarat sa gasesti cusur judecatii Mele? Incinge-ti deci coapsele ca un viteaz si Eu ...

30.000 de clujeni au asistat pe Cluj Arena la un regal fotbalistic. Un "Mondial" mai mic la Cluj le-a amintit clujenilor ce inseamna fotbalul
www.stiridecluj.ro - Cluj
Treizeci de mii de oameni s-au adunat pe Cluj Arena, demonstrand ca fotbalul este intr-ade...

În 22 iunie: Ședinţă a Consiliului Local Alba Iulia: Reabilitarea unor străzi, construirea unei grădiniţe şi a unui supermarket,proiecte pentru ”Smart City” – pe Ordinea de zi
ziarulunirea.ro - Alba
Consiliul local al municipiului Alba Iulia este convocat în şedinţă ordinară, pe data de 22 iunie 2018. Între cele 41 de proiecte de pe Ordinea de zi se află: reabilitarea unor străzi, construirea unei grădiniţe şi a unui supermarket, proiecte pentru ”Smart City”. Proiecte de hotărâri privind : 1. Rectificarea bugetului general de venituri şi […]

Ce a făcut ELODIA înainte de MOARTEA NĂPRAZNICĂ. Descoperirea care ARUNCĂ în AER tot ce ştiai
evz.ro - Bucureşti
S-a aflat totul despre Elodia. O nouă ipoteză se conturează pe baza celor mai recente descoperiri. Anchetatorii sunt uimiţi de acest posibil final....

Depozit de proiectile de 150 mm, descoperit de căutatorii de comori
www.desteptarea.ro - Bacău
Echipa pirotehnică din cadrul Inspectoratului pentru Situaţii de Urgenţă “Mr. CONSTANTIN ENE” al Judeţului Bacău a fost solicitată să intervină în pădurea din comuna Oituz, după ce un grup de detectorişti amatori a descoperit o cantitate importantă de elemente de muniţie rămasă neexplodată în timpul conflictelor militare. În locul marcat de către detectoristi, pompierii pirotehnişti …

30.000 de clujeni au asistat pe cluj Arena la un regal fotbalistic. Un "Mondial" mai mic la Cluj le=a amintit clujenilor ce inseamna fotbalul ade
www.stiridecluj.ro - Cluj
Treizeci de mii de oameni s-au adunat pe Cluj Arena, demonstrand ca fotbalul este intr-ade...

Live-ul nu e viaţă! Şoferii care fac live-uri la volan ristă suspendarea permisului pentru trei luni
www.ebihoreanul.ro - Bihor
Lăsaţi Facebook-ul la o parte când urcaţi la volan! Deputatul PMP Petru Movilă a depus în Parlament un proiect de modificare a OUG 195/2002 privind circulaţia pe drumurile publice în sensul introducerii unui aliniat care să prevadă sancţionarea cu suspendarea vreme de 90 de zile a dreptului de a conduce autovehicule pentru şoferii prinşi sau identificaţi ulterior pe baza postărilor că au folosit telefoanele mobile pentru transmisiuni live sau înregistrări în timp ce conduc.

Realizarea autostrăzii Comarnic – Braşov rămâne o poveste PSD de adormit copiii
feedproxy.google.com - Braşov
Niciodată o investiţie la nivel naţional nu a fost mai reclamată de români, precum autostrada Bucureşti – Braşov. Am ajuns de râsul lumii la viteza cu care se construiesc autostrăzi în România. tocmai când lumea începuse să spere că lucrurile au intrat pe un făgaş normal, după ce s-a anunţat protocolul cu Banca Mondială, PSD

Declaraţie-BOMBĂ despre VLASE, propus şef la SIE. „NU e OMUL STATULUI PARALEL. A fost VÂRF de LANCE în Parlament”
evz.ro - Bucureşti
Codrin Ștefănescu, secretarul general adjunct PSD, a declarat, pentru MEDIAFAX, că nu se poate face o comparaţie între numirea lui George Maior la SRI şi no...

ASF: Active în valoare de 43 de miliarde de lei la fondurile de pensii private obligatorii, la 30 aprilie 2018
ziarulunirea.ro - Alba
Potrivit datelor Autorităţii de Supraveghere Financiară (ASF), fondurile de pensii private obligatorii aveau active în valoare de aproximativ 43,04 miliarde de lei, la 30 aprilie 2018, în creştere cu 23,84% faţă de nivelul de la 30 aprilie 2017. Titlurile de stat deţin cea mai mare pondere în cadrul activelor, de 25,93 miliarde de lei, respectiv […]

Un şofer s-a răsturnat cu maşina în Tîrgu Mureş
www.zi-de-zi.ro - Mureş
În această dimineaţă, pompierii din Detaşamentul Tîrgu Mureş au asigurat măsurile PSI la un accident

COȘMARUL lui DRAGNEA. Cozmin Guşă: De ce NU PARE o OPȚIUNE bună SUSPENDAREA lui IOHANNIS
evz.ro - Bucureşti
Consultantul politic Cozmin Guşă a vorbit despre scenariile suspendării preşedintelui Klaus Iohannis, iar concluzia este că Liviu Dragnea nu este avantajat ...

Cine l-a dat afară pe Adrian Mutu de la FC Voluntari: „L-au lucrat cârtiţele”
evz.ro - Bucureşti
Adrian Mutu şi-a început cu stângul cariera de antrenor. „Briliantul” a fost demis de la FC Voluntari, chiar dacă a reuşit să-i menţină pe ilfoveni în Liga ...

Ziua de 17 iunie a fost declarata Ziua mondiala pentru combaterea desertificarii si a secetei
www.ziuaconstanta.ro - Constanţa
Ziua de 17 iunie a fost declarata Ziua mondiala pentru combaterea desertificarii si a secetei de catre Adunarea Generala a Organizatiei Natiunilor Unite, printr-o rezolutie adoptata in decembrie ...

Localităţile din judeţul Neamţ care rămân FĂRĂ CURENT în perioada 18 – 24 iunie
www.stiri-neamt.ro - Neamţ
Delgaz Grid (E.ON) anunţă: Pentru executarea unor lucrări la instalaţiile de distribuţie în condiţii de siguranţă sunt necesare întreruperi temporare în

Parcul Central din Cluj a fost luminat de mii de lumanari in cadrul Festivalului Luminii
www.stiridecluj.ro - Cluj
Miii de lumanari au fost aprinse aseara pe aleile Parcului Central, pentru ca oamenii sa r...

Spărgătorul din Olt, arestat preventiv
www.ziarulargesul.ro - Argeş
Aşa cum v-am informat, poliţişti ai Secţiei Rurale Lunca Corbului au condus la sediul subunităţii pentru audieri un bărbat din judeţul Olt, suspectat de furt. Este vorba despre Mihai Ş., de 35 de ani, din comuna Valea Mare, bănuit că, în noapte de 3/4 iunie, ar fi pătruns prin efracţie într-o...

”Eroi bistriţeni şi năsăudeni în Marele Război”, expoziţie la Muzeu
www.timponline.ro - Bistriţa-Năsăud
Vernisajul expoziţiei "Eroi bistriţeni şi năsăudeni în Marele Război 1914-1918", eveniment cultural realizat de Complexul Muzeal Bistriţa-Năsăud în colaborare cu Arhivele Naţionale Bistriţa-Năsăud şi asociaţiile „Prospectorii Istoriei” şi „Exploratorii Transilvaniei”, are loc miercuri 20 iunie, de l

Motociclist rănit în sens giratoriu
www.ziarulargesul.ro - Argeş
Un accident s-a produs în cartierul piteştean Găvana, soldat cu rănirea unui motociclist. Din primele verificări a rezultat că evenimentul a avut loc în sensul giratoriu de la fostul Cinematograf "Lumina", unde un motociclist a fost lovit de o maşină. Victima a ajuns la Spitalul Judeţean, iar...

Ziua Justiţiei, pe 1 iulie. Câţi bani vor fi alocaţi de ministerul de resort pentru acest scop
evz.ro - Bucureşti
Acesta este un proiect de lege lansat în dezbatere publică de Ministerul Justiţiei. ...

Topul alimentelor care te ajută să mănânci mai puţin şi să slăbeşti
evz.ro - Bucureşti
Andreea Sava, jurnalista Antena 3, a realizat pe blogul său un top al alimentelor care te ajută să mănânci mai puţin şi să slăbeşti. ...

ISU Neamţ: Trei incendii stinse de pompieri în Roman şi Piatra Șoimului
www.stiri-neamt.ro - Neamţ
Sâmbătă, 16.06.2018, la ora 19:58, Dispeceratul Integrat ISU - Ambulanţă al judeţului Neamţ a fost anunţat prin numărul unic pentru apeluri de urgenţă

EXPLOZIE într-un CLUB! 17 tineri şi-au pierdut viaţa
newsar.ro - Arad
Citeşte azi ce scriu ziarele de mâine!

”Iarba Fiarelor”, un proiect muzical inedit, în seara aceasta la Bistriţa Armonia Jazz 4.0
www.timponline.ro - Bistriţa-Năsăud
”Bistriţa Armonia Jazz”, ediţia 2018, se încheie duminică 17 iunie cu un proiect muzical inedit. Începând cu ora 19.00, în zona foişorului din Parcul Municipal, bistriţenii sunt invitaţi să savureze ”iarba Fiarelor”.
„Iarba Fiarelor” este un proiect muzical care s-a născut vara trecută, dezvoltân

Reactia conducerii Colegiului Mihai Eminescu din Constanta, dupa dezastrul descoperit in urma controlului OPC
www.ziuaconstanta.ro - Constanţa
Un chiosc aflat langa Liceul Mihai Eminescu din municipiul Constanta si o unitate unde erau preparate produsele vandute la chiosc, au fost inchise temporar saptamana trecuta de Comisariatul pentru ...

Hurduzeu nu greşeşte, decât când munceşte!
expressdebanat.ro - Caraş-Severin
„Numai cine nu munceşte nu greşeşte! Uite că aveţi şi titlu pentru articol!“, ne-a aruncat-o cu aplomb jurnalistic preşedintele Silviu Hurduzeu, după ultima şedinţă extraordinară a Consiliului Judeţean.

Donald Trump l-a amenintat pe Shinzo Abe ca-i trimite 25 de milioane de mexicani
ziarmm.ro - Maramureş
Presedintele american Donald Trump l-a amenintat pe premierul japonez Shinzo Abe ca-i va trimite 25 de milioane de mexicani, acesta fiind unul dintr-o serie de mesaje bizare care i-au socat pe ceilalt

ALDE Iaşi şi-a ales o nouă conducere
evz.ro - Bucureşti
Deputatul Varujan Vosganian a fost ales preşedintele filialei ALDE Iaşi, în urma unui scrutin de vot organizat, sâmbătă, în cadrul Conferinţei judeţene pent...

SCANDAL în lumea jurnaliştilor. PREȘEDINTELE UNIUNII ZIARIȘTILOR este URMĂRIT PENAL
evz.ro - Bucureşti
Scandal în cea mai mare organizaţie a jurnalistilor din România. Preşedintele Uniunii Ziariştilor Profesionişti este urmărit penal pentru înşelăciune....

Iată cum arată CLASAMENTUL celor mai ATRĂGĂTOARE oraşe din România
evz.ro - Bucureşti
O analiză realizată de urbanizehub.ro ne arată că oraşele din ţară pot fi şi... sexy. Sursa citată a întocmit chiar şi o irerahie în acest sens....

Voluntarii unei asociaţii din judeţul Neamţ, acuzaţi că fură copiii ca să le ia organele
www.stiri-neamt.ro - Neamţ
Săptămâna trecută, voluntarii unei asociaţii din judeţul Neamţ au fost acuzaţi, pe Facebook, că se folosesc de un microbuz pentru a răpi copii din zona

Cristina Iurişniţi a avut oaspeţi din Bistriţa la Parlament
www.timponline.ro - Bistriţa-Năsăud
”Am deschis porţile Parlamentului pentru un grup de 60 de liceeni între 14-16 ani din Bistriţa. O lecţie de democraţie, prin accesul în sălile impozante ale Camerei Deputaţilor cu explicaţii, cifre, de la Plen până la Sala grupului Parlamentar USR. Deputaţi pentru câteva minute si cu Constituţia Rom

AVERTISMENTUL meteorologilor: Ce ne aşteaptă ASTĂZI (VEZI HARTA FENOMENELOR METEO)
newsar.ro - Arad
Citeşte azi ce scriu ziarele de mâine!

Propunere legislativa. Elevii si studentii care lucreaza in turism, scutiti la plata impozitului si a asigurarilor sociale
www.ziuaconstanta.ro - Constanţa
Senatorul USR de Constanta, Dinu Nicoleta Ramona, cu sustinerea colegilor parlamentari, a depus o initiativa legislativa prin care isi propune sa vina in sprijinul operatorilor din turism care se ...

Angela Merkel caută soluţii la problema Migraţiei. Germania cere reuniune de urgenţă
evz.ro - Bucureşti
Cancelarul german, Angela Merkel, doreşte o grabnică întâlnire între mai multe state europene, scopul fiind legat de problema migraţiei. ...

După ce a fost dat afară din partid, Zamfir a anunţat că demisionează din PNL
feedproxy.google.com - Braşov
Senatorul de Braşov Daniel Zamfir, a anunţat, pe pagina de Facebook, că demisionează din PNL. Asta după ce iniţial a fost demis de conducerea partidului şi aştepta un punct de vedere din partea conducerii formaţiunii politice. Iată mesajul lui Zamfir: „Dragi colegi liberali, Lucrurile pe care le trăim împreună de o bună bucată de vreme

Trei eleve din Cluj-Napoca au castigat un concurs de start-up-uri! Vezi pentru ce proiect au reusit niste copii sa obtina finantare
www.stiridecluj.ro - Cluj
eleve, cluj, proiect, start-up, reciclare

După ce a fost dat afarî din partid, Zamfir a anuţat că demisionează din PNL
feedproxy.google.com - Braşov
Senatorul de Braşov Daniel Zamfir, a anunţat, pe pagina de Facebook, că demisionează din PNL. Asta după ce iniţial a fost demis de conducerea partidului şi aştepta un punct de vedere din partea conducerii formaţiunii politice. Iată mesajul lui Zamfir: „Dragi colegi liberali, Lucrurile pe care le trăim împreună de o bună bucată de vreme

Accesorii vestimentare din pet-uri. Proiectul câştigător la primul accelerator de afaceri din România destinat liceenilor
evz.ro - Bucureşti
Din pet-uri să facem accesorii vestimentare. Iată în esenţă ideea celor trei eleve din Cluj care au câştigat primul concurs de start-up-uri din România destinat liceenilor. ...

Ploaia a surpat terasa unui bloc din Craiova
evz.ro - Bucureşti
Polile abundente din ultimele zile au provocat o alunecare de teren în municipiul Craiova, fiind afectată o parte din terasa unui bloc de locuinţe...

O noua editie a Festivalului International Miturile Cetatii“ incepe pe 20 iunie la Constanta
www.ziuaconstanta.ro - Constanţa
O noua editie a Festivalului International Miturile Cetatii incepe pe 20 iunie. Timp de o saptamana, festivalul se va desfasura pe scenele Teatrului de Stat Constanta, in Piata Ovidiu, in zona ...

Reacţie a conducerii ABA Crişuri după ce BIHOREANUL a dezvăluit kitsch-ul de lux al hotelului cu circuit închis din Băile Felix
www.ebihoreanul.ro - Bihor
La cinci zile după ce BIHOREANUL a dezvăluit felul în care un munte de bani - aproape 1 milion de euro din fonduri publice - a fost „înghiţit” de o construcţie din Băile Felix a Administraţiei Bazinale de Ape Crişuri botezată „Centru de formare şi pregătire”, dar în realitate un hotel cu circuit închis pentru propriii angajaţi, conducerea instituţiei a oferit explicaţii cu privire la investiţia făcută. Datele confirmă, practic, informaţiile prezentate în articolul „Kitsch de lux”.

SimONE, number ONE
www.desteptarea.ro - Bacău
Ca şi în 2017, Simone Tempestini şi-a adjudecat etapa băcăuană a Campionatului Naţional de Raliuri Dunlop. Pilotul Napoca Rally Academy s-a instalat şi în fruntea clasamentului general, depăşindu-l pe Vali Porcişteanu Podium identic În 2018, la fel ca în 2017. Pentru a-l doilea an la rând, Simone Tempestini triumfă în Raliul Moldovei powered by Dedeman. …

Un proiect de Hotărâre CL Alba Iulia propune NEAVIZAREA PUZ-ului pentru Lidl. Dacă va fi aprobat, supermarketul NU va mai fi construit în centrul municipiului
ziarulunirea.ro - Alba
PUZ-ul pentru construirea supermarketului Lidl, în centrul municipiului Alba Iulia, a primit aviz nefavorabil din partea Comisiei de organizare si dezvoltare urbanistica şi Comisiei tehnice de urbanism, iar consilierii locali trebuie să decidă, în şedinţa din 22 iunie, dacă ţin cont de această decizie. În cazul în care CL Alba Iulia va aproba Hotărârea în […]

Nava-Școala Mircea va acosta luni – 18 iunie in Portul Tivat din Muntenegru
www.ziuaconstanta.ro - Constanţa
De la plecarea sa din Portul Constanta, Nava-Scoala Mircea a navigat in cinci mari, Marea Neagra, Marea Marmara, Marea Egee, Marea Ionica si Marea Adriatica, iar cadetii romani si germani au ...

Pensiile speciale pentru aleşii locali, văzute diferit de primarii Nelu Popa şi Felix Borcean
expressdebanat.ro - Caraş-Severin
Primarul Caransebeşului este, în principiu, de acord cu pensiile speciale pentru aleşii locali, pe când primarul Reşiţei, Nelu Popa, nu! Felix Borcean spune că el personal nici nu se bucură, nici nu ar fi trist dacă acest act normativ nu s-ar aproba.

O pictura murala de 72 de metri patrati a fost realizata de peste 60 de elevi din Cluj. O puteti vedea in curtea Colegiului National George Cosbuc
www.stiridecluj.ro - Cluj
Marea Pictură Murală a Elevilor „Revolutia Ultima” - care este este ...

Seminar despre tratarea alcoolismului şi a altor dependenţe, prin Programul terapeutic „Minnesota“
www.desteptarea.ro - Bacău
Sâmbătă, 16 iunie, de la ora 9, la Centrul „Oxigen“ din Bacău a avut loc un seminarul „Terapia dependenţei de alcool/drog- o abordare holistică- Modelul Minnesota”. La eveniment a participat şi a susţinut un punct de vedere şi cunoscutul psihiatru Florin Ene, de la Spitalul Clinic de Psihiatrie „Al. Obregia“ din Bucureşti. La eveniment au …

20 de români şi polonezi acuzaţi că fură peşte din lacurile englezeşti
evz.ro - Bucureşti
Un grup de români fură crapi din iazuri, pescuind ilegal în Marea Britanie, după care se laudă cu peştii pe Facebook, relatează Daily Mail...

VREMEA. ANM a făcut anunţul de care NE TEMEAM cu toţii. ROMÂNIA, VICTIMA furtunilor VIOLENTE
evz.ro - Bucureşti
Se pare că vremea rămâne schimbătoare în continuare, furtunile violente fiind la ordinea zilei.. ANM a făcut anunţul de care ne temeam cu toţii....

Sub privirile nepăsătoare ale SRI, Înalt Trădătoarea Viorica Dăncilă continuă să Înalt Trădeze de o lună de zile. Gândul lui Ion Cristoiu
evz.ro - Bucureşti
Pe 17 mai 2018, preşedintele PNL, Ludovic Orban a anunţat într-o conferinţă de presă depunerea unei plîngeri penale împotriva premierului Viorica Dăncilă......

Angajatii de la Șantierul Naval Mangalia protesteaza saptamana viitoare
www.ziuaconstanta.ro - Constanţa
Sindicatului Liber Navalistul, informeaza printr-un comunicat de presa ca peste 600 de persoane si-au exprimat dorinta de a participa la un protest, miercuri 20 iunie 2018, in Piata Republicii din ...

Vaslui. MĂCEL făcut de o HAITĂ de MAIDANEZI. Păţania ÎNGROZITOARE a unui cioban
evz.ro - Bucureşti
Pagubă importantă pentru un crescător de animale din comuna Banca, judeţul Vaslui, după ce mai multe oi şi capre au fost sfâşiate de o haită de câini...

DOUĂ SEISME au lovit ROMÂNIA în timpul NOPȚI. Ce MAGNITUDINE a avut fiecare CUTREMUR
evz.ro - Bucureşti
CUTREMUR. Două seisme au lovit România în timpul nopţi, primul având o magnitudine de 3,7 grade pe scara Richter, în timp ce cel de-al doilea a avut o inten...

Peste 197.000 de autoturisme second hand, inmatriculate pana in luna mai, in Romania
ziarmm.ro - Maramureş
Inmatricularile de autoturisme rulate au scazut, in primele cinci luni ale anului, cu peste 8%, ajungand pana la 197.010 unitati, comparativ cu aceeasi perioada din 2017, cand erau consemnate circa 21

Călimanii, în floare. Crinii de pădure şi bulbucii de munte fac drumeţiile şi mai frumoase (FOTO)
www.timponline.ro - Bistriţa-Năsăud
În Călimani, au înflorit crinii de pădure şi bulbucii de munte. I-a descoperit Albert Gavrilă urcând de la Colibiţa, pe Dealul Blajului, spre Poiana Iovu, Dealul Pietrei (1168 m), spre aria protejată Piatra Mare, Vârful Ariniş (976 m) şi înapoi la Colibiţa. Durata traseului a fost de circa 6 ore. Ac

FOTOGALERIE. Caravana TIFF 2018: Sătmărenii, prezenţi în număr mare pe Pasajul ,,Corneliu Coposu”
portalsm.ro - Satu Mare
Caravana TIFF 2018: Sătmărenii, prezenţi în număr mare pe Pasajul ,,Corneliu Coposu''

“Charleston, cel mai asteptat film al verii, ruleaza astazi la Constanta in prezenta Anei Ularu si a lui Andrei Cretulescu.
www.ziuaconstanta.ro - Constanţa
Charleston , cel mai asteptat film al verii, va rula duminica, 17 iunie, ora 21 00, la Cinema Cityplex din Constanta. Evenimentul va avea loc in prezenta actritei Ana Ularu si a regizorului Andrei ...

Ce meciuri de disputa astazi in cadrul Campionatului Mondial de fotbal
www.ziuaconstanta.ro - Constanţa
Trei partide cu miza importanta se dispute astazi, in cadrul Campionatului Mondial de fotbal din Rusia, duminica, In primul meci al zilei, in Grupa E, de la ora 15, la Samara, se vor intalni Costa Rica si ...

Consulatul onorific al Estoniei la Constanta inaugurat de premierii Dancila si Ratas
www.ziuaconstanta.ro - Constanţa
Biroul de presa al Guvernului Romaniei transmite prin intermediul unui comunicat de presa, ca premierul Viorica Dancila participa astazi de la ora 11.00, alaturi de prim-ministrul eston J ri Ratas, la ...

VASLUI. O haită de maidanezi a măcelărit zeci de oi
evz.ro - Bucureşti
Pagubã importantã pentru un crescãtor de animale din comuna Banca, judeţul Vaslui, dupã ce mai multe oi şi capre au fost sfâşiate de o haitã de câini maidanezi ...

Peste 116.000 pensionari in Maramures, in luna mai
ziarmm.ro - Maramureş
Datele statistice ale Casei Nationale de Pensii releva ca la nivelul judetului nostru au fost inregistrati in luna mai peste 116.000 de pensionari, se arata intr-un comunicat al Prefecturii Maramures.

Cioban cu 200 de oi, în pericol sa fie luat de apele Siretului
www.jurnaldevrancea.ro - Vrancea
Pompierii din cadrul Secţiei de Pompieri Adjud au fost solicitaţi să intervină pentru salvarea unui cioban surprins de creşterea râului Siret la Adjud.

ELECTRICA: Localităţile din judeţul Alba în care sunt programate întreruperi ale energiei electrice în perioada 18-24 iunie 2018
ziarulunirea.ro - Alba
Localităţile din judeţul Alba în care sunt programate întreruperi ale energiei electrice în perioada 18-24 iunie 2018. Sucursala de Distribuţie a Energiei Electrice Alba anunţă întreruperile programate pentru perioada 18.06.2018-24.06.2018. Motivul acestor întreruperi îl constituie lucrările de întreţinere, revizii, reparaţii efectuate în instalaţiile electrice din zonele respective. Întreruperile programate sunt afişate şi pe site-ul www.sdeets.ro […]

Vrancea s-a cutremurat din nou. Patru seisme în ultimele 24 de ore
www.jurnaldevrancea.ro - Vrancea
Potrivit Institutului Naţional pentru Fizică a Pământului, în ultimile 24 de ore au fost înregistrate patru seisme. Cel mai important dintre acestea a fost

Cutremur semnificativ în România. A fost al şaselea ca magnitudine din acest an
www.stiri-neamt.ro - Neamţ
Un cutremur cu magnitudinea 3,7 pe scara Richter s-a produs duminică, la ora 00:40:37 (ora României), în judeţul Vrancea, zona seismică Vrancea, la o

Adrian Torma, la jumătatea drumului! Socoteala de-acasă nu se potriveşte cu cea din… primărie!
expressdebanat.ro - Caraş-Severin
Ieşit învingător la alegerile locale din 2016, Adrian Torma, edilul oraşului de pe Dunăre, recunoaşte că filmul de acasă nu bate deloc cu realitatea din teren.

Duminică, Sfinţii Mucenici Manuil, Savel şi Ismail sunt pomenţi de creştinii ortodocşi
ziarulunirea.ro - Alba
Sfinţii Manuil, Savel şi Ismail au fost trei fraţi persani, născuţi din tata păgân şi mama creştină. Mama sa i-a botezat în credinţa creştină. Aceşti fraţi erau ofiţeri la curtea împăratului persan. Ei au fost trimişi de împărat către Iulian Apostatul (361-363) spre a negocia şi consfinţi un tratat de pace între imperiul persan şi […]

Războiul româno-român continuă. România când o reconstruim? Editorial de DAN ANDRONIC
evz.ro - Bucureşti
România şi războiul româno-român. Ultima perioadă de acalmie politică cred că am înregistrat-o în 2001, anul alegerilor câştigate de PSD atât la preşedinţie...

Cum îşi astupă Primăria Bistriţa urmele după ce a tăiat copacii de aliniament stradal (FOTO-VIDEO)
www.timponline.ro - Bistriţa-Năsăud
Mai mulţi copaci de aliniament stradal au fost tăiaţi de pe Bulevardele Republicii, Independenţei şi de pe strada Gării, iar în loc să planteze alţii în locul lor, aşa cum prevede legea, Primăria Bistriţa a decis să astupe locurile în care aceştia au crescut cu pietriş şi dale.
Marius Bălan

Judetul Constanta. O soferita si-un sofer, ambii beti, si-au incercat, azi noapte, tablele masinilor in intersectie. Iata ce a iesit
www.ziuaconstanta.ro - Constanţa
Accident Negru Voda pe Soseaua Constantei

„Frăţia drumului” merge mai departe: „Ploaia ne-a potopit şi ne-a zăpăcit”
www.timponline.ro - Bistriţa-Năsăud
Alin Uşeriu, Mircea Miclea, Toma Farcane şi Voicu Bojan au străbătut deja pe jos mai bine de 82 de km din Via Transilvanica în ceea ce numesc ei "Frăţia Drumului". După ce au fost udaţi până la piele de o ploaie, au ajuns la Monor.
"Dragi prieteni, salutări din Monor. Suntem la Primărie şi ne pre

Cutremur semnificativ in Romania. A fost al saselea ca magnitudine din acest an
www.ziuaconstanta.ro - Constanţa
Cutremur Vrancea, Cutremur Romania

Incendiu la un apartament din Medgidia. Doua victime. Ce spun pompierii
www.ziuaconstanta.ro - Constanţa
Incendiu Medgidia strada Decebal




































































































![Neamţ: Accident filmat în direct. A traversat pe roşu şi a fost lovită de o maşină [VIDEO]](/showimg/300-200--zi/images/fullinfo.ro-images/news-186957.jpg)




















![Aur pentru viitorul Reşiţei! Tinerele handbaliste de la Liceul „Traian Vuia“ sunt campioane naţionale! [FOTO/VIDEO]](/showimg/300-200--zi/images/fullinfo.ro-images/news-186936.jpg)

![Neamţ: Se schimbă indicatoarele de direcţionare pe toate traseele turistice din Masivul Ceahlău [FOTO]](/showimg/300-200--zi/images/fullinfo.ro-images/news-186713.jpg)

















































































![Sute de credincioşi, prezenţi la Mănăstirea Petru-Vodă, cu prilejul pomenirii părintelui Justin Pârvu [VIDEO]](/showimg/300-200--zi/images/fullinfo.ro-images/news-186611.jpg)





































































































